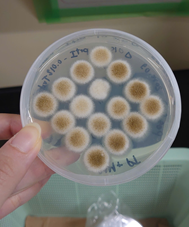

プログラム生の活動
プログラム生の活動
更新日:2026年1月20日
卓越大学院プログラムGD5年永井麻実さん(山口研)が「インドの下水処理施設を対象とした処理性能および環境リスクの評価」というテーマでプロジェクトリーダー実習を実施しました
卓越大学院プログラムGD5年永井麻実さん(山口研、京都府立大出身)が、2025年12月3日~2025年12月29日に、鹿児島高専および国立水文学研究所(ルールキー、インド)において「インドの下水処理施設を対象とした処理性能および環境リスクの評価」というテーマでプロジェクトリーダー実習を実施しました。本研究では,バラナシにある下水処理場およびガンジス川の水を対象にサンプリング・水質検査を実施し、ガンジス川流域の健康へのリスク評価に繋げます。今回のインド視察では下水処理場担当者からも管理方法や現状について話を聞きました。
![]() |
![]() |
![]() |
更新日:2026年1月16日
Overseas Internship Experience in Geotechnical Engineering Practice in Singapore
As part of the NUT-SPRING overseas internship program, I undertook practical training at the Singapore Branch of Kiso-Jiban Consultants Co., Ltd. from 8 to 19 December 2025. During the internship, I observed the laboratory working environment and the general workflow of geotechnical investigation projects. I was introduced to laboratory organization, safety management, and teamwork among engineers and staff. I also observed testing activities and data handling processes used in professional practice. This experience helped me understand real engineering workplaces and international professional standards. The internship was valuable for my future research and professional development as a doctoral student.
概要
NUT-SPRINGプログラムD3 MD SHOHRAB HOSSAIN PAVELさん(豊田研)が地盤工学実務についてプロジェクトリーダー実習を実施しました
NUT-SPRINGプログラムD3 MD SHOHRAB HOSSAIN PAVELさん(豊田研)が、2025年12月8日から19日までの12日間、基礎地盤コンサルタンツ株式会社シンガポール支社にてプロジェクトリーダー実習を実施しました。本実習では、地盤調査プロジェクトにおける実験室作業環境と一般的な業務フローを観察しました。実験室の組織体制、安全管理、技術者・スタッフ間のチームワークについて紹介を受けました。さらに、専門的な実務における試験活動やデータ処理プロセスを観察しました。この経験を通じて、実際のエンジニアリング現場と国際的な専門基準を理解することができました。博士課程学生としての今後の研究と専門能力開発にとって貴重な機会となりました。
![]() 研究所スタッフとの集合写真 |
![]() 実験室検査手順の観察 |
更新日:2025年1月6日
卓越大学院プログラムGD4年Praveen Amodya Ekanayake さん(中山研)が大学院教育改革フォーラム2025に参加し、学生グループ発表で特別賞を受賞しました
卓越大学院プログラムGD4年Praveen Amodya Ekanayake さん(中山研)が2025年12月12・13日に大学院教育改革フォーラム2025に参加しました。本フォーラムでは、「専門知の統合による社会課題へのアプローチ」という課題に対し、「DNAから食卓へ:個人仕様で持続可能な食事設計」をテーマとした分野横断的な提案をグループとして発表しました。その発表内容が高く評価され、特別賞を受賞しました。本経験を通じて、学術研究を社会的ニーズと結びつけるための貴重な知見を得ることができました。
As part of the WISE Program, I, Praveen Amodya Ekanayake participated in the Graduate School Educational Reform Forum 2025. Our group presented an interdisciplinary proposal addressing social challenges through the integration of specialized knowledge. The presentation was highly evaluated, and our group received the Special Award in the student session. This experience provided valuable insights into connecting academic research with societal needs.
![]() |
![]() |
![]() |
更新日:2026年1月5日
卓越大学院プログラムD3小岩滉宜さん(庄司研、一関高専出身)が、The International Chemical Congress of Pacific Basin Societies 2025(Pacifichem 2025)に参加し、学会発表を行いました
卓越大学院プログラムD3小岩滉宜さん(庄司研、一関高専出身)が、2025年12月15日から12月20日までハワイのホノルルで開催されたThe International Chemical Congress of Pacific Basin Societies 2025(Pacifichem 2025)に参加し、情報収集を行うとともに、 「DNA Nanopore Tethered Electrode for Efficient Nanopore Insertion into Target Liposomes」と題する研究発表を行いました。発表では、DNAナノポアを修飾した金ニードルをリポソームに接触させることでリポソーム膜中に物理的にナノポアを挿入する手法を提案し、本手法におけるナノポアの挿入確率について調査した結果を報告しました。
|
口頭発表の様子 |
更新日:2025年12月8日
卓越大学院プログラムGD5年豊場亮太さん(大塚研)「不均一に形成される欠陥群のネットワーク特徴量解析と金属積層造形材の特性予測」というテーマでプロジェクトリーダー反復実習を実施しました
卓越大学院プログラムGD5年豊場亮太さん(大塚研、岐阜高専出身)が2025年11月4日から11月28日までの約4週間、島根大学にて「不均一に形成される欠陥群のネットワーク特徴量解析と金属積層造形材の特性予測」というテーマでプロジェクトリーダー反復実習を実施しました。本実習では、金属積層造形物の機械的特性に影響を及ぼすボイドの成長過程を解明するため、流体解析とネットワーク特徴量評価を組み合わせた解析手法を検討しました。具体的には、ボイド直径とそのばらつきに起因する合体成長確率推移の高速計算手法、得られた結果に基づく臨界バブル直径とその影響について議論しました。 国内外の大学や研究機関との共同研究を継続的に行う中で、変化を恐れず挑戦しつづける研究者としての在り方も学ぶことができ、非常に貴重な機会となりました。
|
最終報告会の様子 |
更新日:2025年11月28日
卓越大学院プログラムGD5年 土田脩斗さん(山田研、長岡高専出身)が、The 36th International Photovoltaic Science and Engineering Conference(PVSEC-36)に参加し、学会発表を行いました
卓越大学院プログラムGD5年 土田脩斗さん(山田研、長岡高専出身)が、2025年11月9日から11月14日までタイのバンコクで開催されたThe 36th International Photovoltaic Science and Engineering Conference(PVSEC-36)に参加し、情報収集を行うとともに、 「Tailor-made solar power output: combining vertical and horizontal PV to match load profiles」と題する研究発表を行いました。発表では、垂直両面型太陽光発電システムと水平単面型太陽光発電システムを組み合わせ,発電プロファイルを電力需要の時間変動に応じて最適化する「負荷適合型PVシステム」の可能性について報告しました。
![]() 学会会場 |
![]() ポスター発表の様子 |
更新日:2025年11月19日
卓越大学院プログラムGD4年 橋本裕朔さん(宮下研)が「パウダーベッドフュージョン式積層造形での複数レーザーが金属材料組織に及ぼす影響の検討」というテーマでプロジェクトリーダー反復実習を実施しました
卓越大学院プログラムGD4年 橋本裕朔さん(宮下研、石川高専出身)が2025年10月19日から11月6日までの約3週間、東金属産業株式会社にて「パウダーベッドフュージョン式積層造形での複数レーザーが金属材料組織に及ぼす影響の検討」というテーマでプロジェクトリーダー反復実習を実施しました。本実習では、複数のレーザーを用いたPBF-LB(パウダーベッドフュージョン金属積層造形)により作製される製品の品質に影響を与える因子の特定に取り組みました。内部欠陥などの品質に影響する因子としてよく知られるレーザーの出力や走査速度に加えて、製品の形状などが表面状態などに影響を与えることが明らかとなり、同プロセスを用いた製品製造に向けた設計の指針を示すための重要な知見が得られました。
|
金属3Dプリンターによる品質評価用サンプル作製の様子 |
更新日:2025年11月19日
卓越大学院プログラムD3年 渡部泰弘さん(坪根研)が「周期的パラメータ変動を伴う非自律時変システムに対するAI予測モデルの学習基盤構築と検証」というテーマで海外リサーチインターンシップを実施しました
卓越大学院プログラムD3年渡部泰弘さん(坪根研)が2025年 8月27日から11月1日までの約2か月間、スペイン・バルセロナのUniversitat Politècnica de Catalunya(UPC)にて「周期的パラメータ変動を伴う非自律時変システムに対するAI予測モデルの学習基盤構築と検証」というテーマで海外リサーチインターンシップを実施しました。本インターンシップでは、周期的パラメータ変動を伴う非自律時変システムに対するAI予測モデルの学習基盤構築と検証を行いました。特に、データ駆動型アプローチ(Reservoir Computingなど)を用いて、車両モデルの時間発展を予測する手法の検討を進めました。
滞在期間中は、研究所内外の博士課程学生や研究者と議論を重ねることで、非定常システムの理論的理解を深めるとともに、国際的な研究環境で求められるプレゼンテーション力や議論力を磨く貴重な機会となりました。日常生活でも多様な文化的背景を持つ人々との交流を通して新たな視野を得ることができ、今後の研究活動や国際共同研究への自信につながる充実したインターンシップとなりました。
|
成果報告後の記念撮影 |
更新日:2025年11月7日
Ms. Huyen Anh Nguyen (HAKKO Science Laboratory – Ogasawara Lab) of the Graduate School of Excellence Program GD3 participated in an overseas research internship from August 1 to September 30, 2025, with the theme “Exploring CRISPR-Cas9 Applications and Small-Scale Sake Fermentation.”
Ms. Huyen Anh Nguyen (HAKKO Science Laboratory – Ogasawara Lab) of the Graduate School of Excellence Program GD3 participated in an overseas research internship from August 1 to September 30, 2025, with the theme “Exploring CRISPR-Cas9 Applications and Small-Scale Sake Fermentation.”
During the internship, she conducted experimental studies at the National Research Institute of Brewing in Hiroshima under the supervision of Dr. Ken Oda (Brewing Microbiology Research Division).
Through this experience, she gained hands-on skills in microbial genetic engineering and fermentation technology, as well as valuable insights into practical research collaboration.
概要
卓越大学院プログラムGD3グエン・フエン・アンさん(小笠原研)が「CRISPR-Cas9の応用と小規模日本酒発酵の探求」というテーマで海外リサーチインターンシップを行いました。
卓越大学院プログラムGD3グエン・フエン・アンさん(小笠原研、ハノイ工科大学出身)が「CRISPR-Cas9の応用と小規模日本酒発酵の探求」をテーマに海外リサーチインターンシップを行いました。
卓越大学院プログラムGD3グエン・フエン・アンさん(小笠原研、ハノイ工科大学出身)が、国立醸造研究所にて2025年8月1日から9月30日までの約2ヶ月間の海外リサーチインターンシップを行いました。本実習は、広島にある国立醸造研究所において、織田健博士(醸造微生物研究部門)の指導のもとで実験的研究を行いました。 この経験を通じて、彼女は微生物遺伝子工学と発酵技術における実践的なスキルを習得するとともに、実用的な研究協力に関する貴重な知見を得ることができました。
![]() With Oda sensei |
![]() A.oryzae (Koji mold) mutants |
更新日:2025年10月30日
卓越大学院プログラムGD5年 味田渉さん(中山研)が、「第1回IGPAC2025」に参加し、学会発表を行いました
卓越大学院プログラムGD5年 味田渉さん(中山研、室蘭工業大学出身)が2025年10月5日から10月9日に三重県の伊勢志摩で開催された、International symposium on Green Processing for Advanced Ceramics (IGPAC) 2025に参加しました。本国際会議は、資源・環境負荷の低減に貢献する無機材料の非平衡プロセスと応用技術に焦点を当て、その基盤となる科学的・技術的知見を議論する国際シンポジウムとして開催されました。研究成果について学会発表を行い、国内外の研究者に対して自身の研究の意義と進捗を説明し、発表後には、参加者との間で具体的なデータや実験手法に関する質疑応答が活発に行われ、今後の研究推進に向けた貴重な示唆を得ることができました。国際的な研究交流の場に参加し、最先端の知見を得るとともに、自らの研究を発信できたことは、今後の研究活動に大きく寄与する経験となりました。
![]() 会場の様子 |
![]() 発表時の様子 |
更新日:2025年10月23日
Mr. Praveen Ekanayake (Nakayama Lab) of the Graduate School of Excellence Program GD3 participated in an overseas development research internship from September 1 to September 30, 2025, with the theme “Development of Adaptive Gait Control for a Hexapod Robot Using Evolutionary Algorithms and Central Pattern Generators.”
Mr. Praveen Ekanayake (Nakayama Lab) of the Graduate School of Excellence Program GD3 participated in an overseas development research internship from September 1 to September 30, 2025, with the theme “Development of Adaptive Gait Control for a Hexapod Robot Using Evolutionary Algorithms and Central Pattern Generators.”
During the internship, he conducted simulation-based studies at the Institute for Safe Autonomy, University of York, UK, under the supervision of Professor Andy Tyrrell.
Through this experience, he learned advanced approaches in robotic locomotion and international research collaboration.
概要
卓越大学院プログラムGD3プラヴィーン・エカナヤケさん(中山研)は「進化的アルゴリズムと中枢パターン生成器(CPG)を用いた六脚ロボットの適応歩行制御の開発」をテーマとして、海外リサーチインターンシップを実施しました。
卓越大学院プログラムGD3プラヴィーン・エカナヤケさん(中山研)は、2025年9月1日から9月30日まで、イギリス・ヨーク大学 Institute for Safe Autonomy において、「進化的アルゴリズムと中枢パターン生成器(CPG)を用いた六脚ロボットの適応歩行制御の開発」をテーマに海外リサーチインターンシップを実施しました。
滞在中は、アンディ・タイレル教授の指導のもと、シミュレーションに基づく研究を行い、ロボット歩行制御および国際的な研究協働の手法を学びました。
|
With Professor Andy Tyrrell |
更新日:2025年10月20日
卓越大学院プログラムGD4加藤大貴さん(伊東研)が「同期リラクタンスモータ向けV/f 制御の開発」というテーマで海外リサーチインターンシップおよび海外発展リサーチインターンシップを行いました
卓越大学院プログラムGD4加藤大貴さん(伊東研、福島高専出身)が、韓国のソウル大学 Electric Energy Conversion Labにて2025年4月7日から2025年10月7日までの約6ヶ月間の海外リサーチインターンシップおよび海外発展リサーチインターンシップを行いました。本実習では、産業用途への普及が期待される同期リラクタンスモータ(SynRM)に対して、より簡便で実装コストが安価なV/f制御の適用に向けた制御手法の開発を目指し数式モデルの構築から並列運転手法まで検証しました。実習先では多くの博士学生と深く議論し専門分野への知識を広げるとともに、日常生活での交流を通して友好関係を深めることができました。
![]() 成果報告後の記念撮影(写真右二番目:GD4加藤) |
![]() 実験システムの様子 |
更新日:2025年10月8日
卓越大学院プログラムGD4 NGUYEN PHAM HONG DAOさんが第12回IWA国際シンポジウムAGRO’2025に参加し、学会発表を行いました。
卓越大学院プログラムGD4年のNGUYEN PHAM HONG DAOさん(山口研、Can Tho University. Degree of Bachelor(ベトナム)出身)が、イスタンブールで開催された第12回IWA国際シンポジウムAGRO’2025に参加し、情報収集を行うとともに、 「Distribution of GHG emissions from production to wastewater treatment process of natural rubber products in Vietnam」と題する研究発表を行いました。 本会議はイスタンブール工科大学および京都大学の共催によって開催されました。 発表では、ベトナムの天然ゴム産業における主要製品のライフサイクルを対象に、生産および廃棄物処理過程に伴う温室効果ガス排出要因を明らかにし、削減に向けた持続可能な方策について報告しました。
![]() 天然ゴム産業のライフサイクルに関する研究ポスター発表の様子 |
![]() 長岡技術科学大学・山口研究室チーム |
更新日:2025年9月19日
卓越大学院プログラムD3岡田瞬さん(庄司研)が「細胞外ATP検出を目指したマイクロ流体システムの開発」というテーマで海外発展リサーチインターンシップを実施しました
卓越大学院プログラムD3の岡田瞬さん(庄司研、米子高専出身)が2025年8月21日~9月5日にシンシナティ大学(オハイオ州、アメリカ)において、「細胞外ATP検出を目指したマイクロ流体システムの開発」というテーマで海外発展リサーチインターンシップを実施しました。実習では、共同研究先の独自技術であるマイクロ金電極と我々の研究室で開発した細胞捕捉用マイクロ流路を組み合わせ、ATP検出実験を行いました。
|
ATP検出実験の様子 |
更新日:2025年9月19日
卓越大学院プログラムD3岡田瞬さん(庄司研)が国際会議「ACS Fall 2025」に参加し,口頭発表を行いました
卓越大学院プログラムD3の岡田瞬さん(庄司研、米子高専出身)が2025年8月17日~8月20日にアメリカのワシントンで開催されたACS Fall 2025で口頭発表を行い、現地の参加者と活発な議論を行いました。
発表タイトル:Construction of liposome-based multicellular structures with specific shapes|
現地の様子 |
更新日:2025年9月4日
卓越大学院プログラムGD2年 樺澤壮太さん(山口研、長岡高専出身)が「極乾燥地域におけるDHSリアクターを用いた灌漑用水生産技術の実証」というテーマで海外リサーチインターンシップを実施しました
卓越大学院プログラムGD2年 樺澤壮太さん(山口研、長岡高専出身)が、2025年6月11日から8月30日まで、チリのUniversidad de AntofagastaのCentro de Bioinnovación de Antofagasta – CBIAにおいて、「極乾燥地域におけるDHSリアクターを用いた灌漑用水生産技術の実証」というテーマで海外リサーチインターンシップを行いました。実習の舞台であったチリ北部は年間降水量が10ミリにも満たない世界一の乾燥地帯であるアタカマ砂漠が広がり、深刻な水資源問題が生じています。実習機関では、下水から高品質の灌漑用水とバイオ肥料を作ることを目的として、DHSリアクターと藻類による環境浄化を組み合わせた水処理実証研究に取り組みました。今後は、本技術の改良と社会実装を目指し、現地研究者との共同研究として継続的に発展させていきます。
|
微細藻類の培養池 |
更新日:2025年9月4日
卓越大学院プログラムGD4年 MARTINEZ SANCHEZ ALEJANDRO ISIDROさん(中山研、メキシコ・モンテレイ大学出身)、GD2年 樺澤壮太さん(山口研、長岡高専出身)がCIBAL 2025に参加し、学会発表を行いました
卓越大学院プログラムGD4年 MARTINEZ SANCHEZ ALEJANDRO ISIDROさん(中山研、メキシコ・モンテレイ大学出身)と、GD2年 樺澤壮太さん(山口研、長岡高専出身)が、2025年8月25日から28日までチリ・アントファガスタで開催された第1回イベロアメリカ藻類バイオテクノロジー会議 (CIBAL 2025) に参加し、口頭発表を行いました。イベロアメリカ諸国では太陽光や沿岸資源を生かした藻類の研究が盛んであり、藻類による高付加価値製品や環境浄化など、多様な知見が共有されました。両名は、自身の研究を藻類分野の視点から議論を深めるとともに、新たな国際ネットワークを構築することができました。
|
会場の様子(写真左:樺澤さん、写真右:アレックスさん) |
更新日:2025年9月2日
卓越大学院プログラムGD5 永井麻実さん(山口研)が「インドにおける下水処理水がガンジス川に与える影響調査」というテーマで海外発展リサーチインターンシップを実施しました
卓越大学院プログラムGD5 永井麻実さん(山口研、京都府立大出身)が、2025年8月9日~2025年8月17日に、国立水文学研究所(ルールキー、インド)において、「インドにおける下水処理水がガンジス川に与える影響調査」というテーマで海外発展リサーチインターンシップを実施しました。本研究では、沐浴場に流れ込む排水路の水を対象にサンプリング・水質検査を実施し、ガンジス川流域の健康へのリスク評価に繋げます。
![]() サンプリングの様子@ハリドワールの沐浴場 |
![]() 国立水文学研究所にて(永井さん:左から3人目) |
![]() 実際にガンジス川で沐浴を実施 |
更新日:2025年9月2日
卓越大学院プログラムD3年 坂口穂貴さん(石橋研)が「磁気光学材料を用いた光学的画像処理デバイスにおけるオンライン学習技術の開発」というテーマでプロジェクトリーダー実習を実施しました
卓越大学院プログラムD3年 坂口穂貴さん(石橋研、奈良高専出身)が2025年7月8日から2025年8月8日までの約1カ月間、東京都世田谷区にあるNHK放送技術研究所において「磁気光学材料を用いた光学的画像処理デバイスにおけるオンライン学習技術の開発」というテーマでプロジェクトリーダー実習を行い、実習機関では、実験装置の構築からオンライン学習の原理検証まで実施しました。
|
磁区記録装置の一部 |
更新日:2025年8月26日
卓越大学院プログラムGD5年 末満堅人さん(南部研)が「運動学習における脳内誤差処理機構の解明」というテーマでプロジェクトリーダー反復実習を実施しました
卓越大学院プログラムGD5年 末満堅人さん(南部研、都城工業高専出身)が2025年7月1日から2025年8月8日までの約1カ月間、情報通信研究機構(NICT)未来ICT研究所脳情報通信融合研究センターにおいて「運動学習における脳内誤差処理機構の解明」というテーマでプロジェクトリーダー反復実習を実施し、実習機関では「おもろい研究」をモットーに、脳と通信を融合させた研究に取り組んでいます。所属した研究室は、脳がどのように運動を制御・学習しているかを解明する基礎研究を行っており、末満さんはその一端として実験設計と解析を担当しました。今回、多様な分野の研究者が集まる環境で研究・キャリア形成に関する議論やネットワーク形成をできたことは、彼自身の研究活動を進めていく上で大きな財産となりました。
|
実習先のロビーに飾られている「おもろい研究」、実習先のモットーである |
更新日:2025年7月3日
卓越大学院プログラムGD5 穂積将輝さん(中山研)が「マルチマテリアル3Dプリント技術を利用した、ロボットハンドエンドエフェクタの作成及びその評価」というテーマで海外発展リサーチインターンシップを行いました
卓越大学院プログラムGD5年 穂積 将輝さん(中山研、宇部高専出身)がイギリスのUniversity of York, Institute of Safe Autonomyにおいて1ヶ月間「マルチマテリアル3Dプリント技術を利用した、ロボットハンドエンドエフェクタの作成及びその評価」というテーマで海外リサーチインターンシップを行いました。
実習先では、最先端のロボットや実験設備を利用し、イギリスのみならず、世界中から集まったPhDの学生や研究者とともにロボットハンドの設計及びその評価を行いました。
GD2の際に海外リサーチインターンシップに参加した経験を活かし、積極的に活動することができました。
![]() 研究室のチューターと |
![]() プレゼンテーションの様子 |
更新日:2025年6月26日
卓越大学院プログラムGD4年 MARTINEZ SANCHEZ ALEJANDRO ISIDROさん(中山研)が「3rd IWA YPA Canada – International Water Association Young Water Professionals」に参加し、学会発表を行いました
卓越大学院プログラムGD4年 MARTINEZ SANCHEZ ALEJANDRO ISIDROさん(中山研、メキシコ・モンテレイ大学出身)が、2025年6月18日から20日までカナダ・エドモントンのアルバータ大学にて開催された、「3rd IWA YWP Canada – International Water Association Young Water Professionals」に参加し、口頭発表を行いました。
また、Young Water Professionals Japan(YWP Japan)のメンバーとして、YWP Japan 会長である京都大学 大学院工学研究科 都市環境工学専攻 助教の野村洋平氏とともに、YWP Canada のメンバーズと交流・意見交換を行いました。
会議には世界各国から多くの研究者が参加し、活発な議論とともに新たな国際ネットワークの構築に繋がる貴重な機会となりました。
![]() 集合写真(アレックスさん:左から2人目) |
![]() YWP ジャパン、YWPカナダ交流会 |
更新日:2025年6月10日
卓越大学院プログラムGD4年 NGUYEN PHAM HONG DAOさん(山口研)が第15回Asian Symposium on Microbial Ecology(ASME)に参加し、学会発表を行いました
卓越大学院プログラムGD4年NGUYEN PHAM HONG DAOさん(山口研、カントー大学出身、ベトナム)が、2025年05月28日から30日まで韓国の清州県で開催された、第15回Asian Symposium on Microbial Ecology(ASME)に参加し学会発表を行いました。発表タイトルは「Microorganism distribution and their in situ activities in anaerobic granular sludge with acetone as the main substrate」。アセトンの嫌気性分解メカニズムに関する革新的な研究成果を発表しました。発表後は、韓国・日本・中国などの微生物学分野の専門家の方々と、議論する機会を得ることができました。
![]() アセトン分解に関する研究のポスター発表 |
![]() 長岡技大の学生と一緒の学会に参加する |
更新日:2025年5月8日
卓越大学院プログラムGD2年永妻志問さん(山口研)が「トッテン氷河域における高EPS生産生物の探査」というテーマで第66次南極地域観測隊に参加し、プロジェクトリーダー実習を実施しました
卓越大学院プログラムGD2年永妻志問さん(山口研、松江高専出身)が、第66次南極地域観測隊の夏隊同行者(レグ2)として、2025年2月22日から2025年4月6日にかけて「トッテン氷河域における高EPS生産生物の探査」というテーマでプロジェクトリーダー実習を実施しました。本実習では、融解が加速するトッテン氷河域にて海水サンプルを採取し、自身の研究知見に基づいた分離培養手法を介して高EPS生産生物の探査を行いました。
乗船した南極観測船「しらせ」では、多様な専門領域から構成される観測隊員および海上自衛隊員と共に生活し、歴史ある南極観測事業に従事する責任感や熱意に心揺さぶられる日々を過ごしました。今回の実習にて得られた知識やマインドセットは、研究活動のみならず、今後の人生設計においても極めて貴重で有意義なものになると確信しています。
![]() トッテン氷河沖にて海洋観測の様子 |
![]() 南極観測船「しらせ」にて |
更新日:2025年5月8日
卓越大学院プログラムGD3年 橋本裕朔さん(宮下研)が「PBF-LB造形プロセス中の酸素濃度が欠陥生成状況に与える影響の評価」というテーマでプロジェクトリーダー実習を実施しました
卓越大学院プログラムGD3年橋本裕朔さん(宮下研、石川高専出身)が2025年1月17日から2025年3月21日までの約2か月間、東金属産業株式会社において、金属3Dプリンターの一種である、PBF-LB(パウダーベッドフュージョン金属積層造形)により作製される製品の品質を向上させるための技術開発を行いました。造形環境の酸素濃度を低減することにより製品内部の欠陥の発生を抑制することに成功しました。また、今後の技術開発により造形環境の制御による製品性能のさらなる向上が見込まれます。
|
金属3Dプリンターで作製された品質評価用サンプル |
更新日:2025年3月14日
卓越大学院プログラムGD2年 椿建己さん(南部研)が「EEG 脳状態遷移の可視化と可聴化によるニューロフィードバック」というテーマでプロジェクトリーダー実習を実施しました
卓越大学院プログラムGD2年椿建己さん(南部研、松江高専出身)が、2024年12月1日から2025年2月28日までの約3カ月間、(株)国際電気通信基礎技術研究所において「EEG 脳状態遷移の可視化と可聴化によるニューロフィードバック」というテーマでプロジェクトリーダー実習を実施しました。実習では、手足が不自由な方などへの文字入力等のBCI応用にむけた新たなラベリング手法を用いた課題判別について解析しました。
|
実習先での発表時の写真 |
更新日:2025年2月26日
卓越大学院プログラムGD3大野貴志さん(伊東研)が「広い入出力電圧範囲に対するマルチモードLLCコンバータの最適設計」というテーマで海外リサーチインターンシップおよび海外発展リサーチインターンシップを行いました。
卓越大学院プログラムGD3大野貴志さん(伊東研,産技高専出身)が、フランスのMITSUBISHI ELECTRIC R&D CENTRE EUROPE(MERCE)にて2024年9月2日~2024年12月26日までの約4か月間の海外リサーチインターンシップおよび2025年1月8日~2025年2月14日の約6週間の海外発展リサーチインターンシップを行いました。 本実習では、広電圧範囲アプリケーション向け絶縁型DC-DCコンバータの小型化・高効率化を目指し、設計手法の最適化や先進制御の適用による性能向上を理論・実験の両面から検証しました。 実習先では多様な専門分野を持つ研究員との議論を通じてパワーエレクトロニクス設計への理解を深めるとともに、日常交流を通じて国際的な視野を広げる貴重な経験を得ることができました。
|
成果報告後のロビーにて(写真左二番目:GD3大野) |
![]() MERCE現地スタッフ(Team wa7ch)との交流(写真左:GD3大野) |
更新日:2025年2月26日
卓越大学院プログラムGD5 蔵下はづきさん(山口研)が台湾の都市下水処理プロセスなどに生息する微生物について、その機能や生態を解明することをテーマに海外リサーチインターンシップおよび海外発展リサーチインターンシップを実施しました。
卓越大学院プログラムGD5 蔵下はづきさん(山口研、都城高専出身)が、台湾の国立成功大学 永續環境實驗所にて2024年11月6日から2025年1月31日まで海外リサーチインターンシップおよび海外発展リサーチインターンシップを行いました。実習では、台湾の都市下水処理プロセスなどに生息する微生物について、その機能や生態を解明することを目指し研究を行いました。実習先の研究室では、Hui-Ping Chuang博士をはじめ、台湾の先生方や研究者との議論を通じて最新の廃水処理微生物生態に関する見識が得られたほか、日常生活での交流により友好関係を深めることができました。
|
大学内の生活排水を貯めておく池 |
![]() 排水を処理するための処理施設およびビオトープ |
更新日:2025年2月20日
Laddu Samadhi Wandana, a third-year WISE Program (GD3) student, is currently engaged in an Practical work for project leader education program in Malaysia
As a GD3 student, Mrs. Samadhi Wandana actively participated in an Practical work for project leader education that lasted approximately one month, from January 14, 2025, to February 07, 2024. This program was conducted under the guidance of Dr. Nurul Fariha at the Water Resources and Environmental System Laboratory, School of Civil Engineering, College of Engineering, Universiti Teknologi MARA (UiTM), Malaysia.
Mrs. Wandana’s research focuses on the “Development of a Sustainable Land-Based Aquaculture System Using Energy-Saving Water Treatment Technology.” This study is part of the UNDP ASEAN Blue Innovation Challenge project, a collaborative initiative awarded jointly to Universiti Teknologi Malaysia, Universiti Teknologi Melaka, and Nagaoka University of Technology. The project will conduct demonstration tests of a circular and sustainable aquaculture system at a land-based aquaculture farm in Malaysia, develop an efficient water treatment system that integrates energy-saving water treatment technology, and support a monitoring system. This research contributes to advancing eco-friendly aquaculture practices while enhancing water resource management.
概要
卓越大学院プログラムGD3年LADDU SAMADHI WANDANAさん(山口研)が省エネルギー水処理技術を用いた持続可能な陸上養殖システムの開発のためプロジェクトリーダー実習を行いました。
卓越大学院プログラムGD3年LADDU SAMADHI WANDANAさん(山口研、スリランカ・スリジャヤワルダナプラ大学出身)が、マレーシアのUniversiti Teknologi MARA (UiTM), College of Engineering, School of Civil Engineering, Water Resources and Environmental System Laboratoryにて、2025年1月14日から2024年2月7日までの約1ヶ月間、Dr. Nurul Farihaの指導のもとプロジェクトリーダー実習を行いました。
この研究は、「省エネルギー水処理技術を用いた持続可能な陸上養殖システムの開発 」に焦点を当てています。マレーシア工科大学、マラッカ工科大学、長岡技術科学大学に共同で授与されたUNDP ASEANブルーイノベーションチャレンジプロジェクトの一環です。本プロジェクトでは、マレーシアの陸上養殖場における循環型・持続可能な養殖システムの実証試験、省エネルギー型水処理技術を統合した効率的な水処理システムの開発、モニタリングシステムの支援を行いました。この研究は、水資源管理を強化しながら、環境にやさしい養殖の実践に貢献するものです。
![]() Conducting laboratory experiments at the Laboratory |
![]() With Dr. Nurul Fariha and laboratory staff |
更新日:2025年2月13日
卓越大学院プログラムGD5 西川滉大さん(伊東研)が「モデル予測制御による同期電動機制御の高性能化に関する研究」テーマで海外(発展)リサーチインターンシップを実施しました
卓越大学院プログラムGD5西川滉大さん(伊東研, 長岡高専出身)が,韓国のAjou University Power Electronics Laboratory にて2024年11月25日~2024年12月27日までの約1ヶ月間の海外リサーチインターンシップおよび,2025年1月6日~1月24日までの約3週間の海外発展リサーチインターンシップを行いました。実習では,家電製品をはじめ日常の様々な場所で使用される同期電動機について,より高効率,より高性能に制御するためのモデル予測制御の開発を目指し研究を行いました。実習先の研究室では,Kyo-Beum Lee 教授をはじめ,たくさんの学生達との議論を通じて同期電動機制御に関する見識が得られたほか,日常生活での交流により友好関係を深めることができました。
![]() |
![]() |
![]() |
更新日:2025年1月21日
卓越大学院プログラムGD5年安原雅貴さん(南部研)が、「音楽聴取中の脳波解析」というテーマでプロジェクトリーダー反復実習を実施しました
卓越大学院プログラムGD5年安原雅貴さん(南部研、長岡高専出身)が、2025年1月6日から1月17日までの約2週間、Sony Computer Science Laboratories, inc.において「音楽聴取中の脳波解析」というテーマでプロジェクトリーダー反復実習を行いました。実習では、脳波から聴いている音楽が個人の嗜好に合っているかどうかを判別することで、ユーザーの操作なしに適当な曲を推薦できるシステムの開発を目指しました。このシステムは、身体を自由に動かすことが難しい方々にも利用可能であり、生体信号を基盤とした次世代の推薦システムとしての開発が進められています。
|
指導してくださった古屋先生(写真右)とDr. Vincent (写真左)との写真 |
更新日:2025年1月6日
卓越大学院プログラムGD3年DAOさん(山口研)が、第14回International Symposium on Southeast Asian Water Environment(SEAWE)に参加し、学会発表を行いました。
卓越大学院プログラムGD3年NGUYEN PHAM HONG DAOさん(山口研、カントー大学出身、ベトナム)が、2024年12月3日から5日までマレーシアのクアラルンプールで開催された、第14回International Symposium on Southeast Asian Water Environment(SEAWE)に参加し学会発表を行いました。本シンポジウムは、東京大学とマラヤ大学の主催によるものです。「Enhancement of anaerobic degradation of acetone in a UASB system by feeding 2-propanol」という発表テーマで、Dao さんは100人の参加者の中から、最優秀発表賞に選ばれました。
|
アジア各国の水環分野の専門家を含む学会発表チーム(DAOさん:右から1人目) |
![]() 授賞式と廃水処理工場への技術視察 |
更新日:2025年1月6日
卓越大学院プログラムGD3年原田隆大さん(山口研)が「有用微生物と未利用バイオマスを用いたバイオスティミュラント技術の開発」というテーマでプロジェクトリーダー反復実習を行いました
卓越大学院プログラムGD3年原田隆大さん(山口研、鹿児島高専出身)が2024年9月9日~9月20日まで鹿児島県長島町の青果会社において「有用微生物と未利用バイオマスを用いたバイオスティミュラント技術の開発」というテーマでプロジェクトリーダー反復実習を行いました。本実習では、ジャガイモ栽培が地域一大産業である鹿児島県出水郡長島町でジャガイモそうか病抑制を目的に、バイオスティミュラント資材の実証試験を行いました。資材は植物成長促進作用とそうか病病原体に対し拮抗作用を有する有用微生物を用いて自作し、実圃場で散布することにより効果を検証しました。さらに、地域の農家と連携し、フィールドワークに適した資材の改良を目指しました。
更新日:2024年11月6日
卓越大学院プログラムGD5年沈志明さん(中山研)が「新規磁性ソフトロボットの開発」というテーマで海外発展リサーチインターンシップを行いました
卓越大学院プログラムGD5年Zhiming Shenさん(中山研、上海大学出身)がイギリスのThe University of Sheffieldにおいて1ヶ月間「新規磁性ソフトロボットの開発」というテーマで海外発展リサーチインターンシップを行いました。 ソフトロボットは高い柔軟性と可動性を備え、医療や工業といった多岐にわたる分野での応用が期待される革新的な技術です。今回のインターンシップを通じて、ソフトロボットに関する基礎から応用に至るまでの幅広い知識を深め、特に材料特性や制御システムに関する要素技術について多くの知見を得ることができました。また、世界トップレベルの研究現場での実務経験を積むことで、チームワークやコミュニケーションの重要性も再認識する機会となりました。
![]() Prof. Shuhei Miyashita研究室メンバー |
![]() 研究室メンバーと食事会 |
更新日:2024年10月18日
Mavin De Silva, third-year student in the WISE Program (GD3) successfully completes Research Internship on Socio-Economic Impacts of EV Charging Stations at New York University: Advancing Urban Resilience.
M. Mavin De Silva, a third-year student in the WISE Program in Nakayama Labaratory, completed an overseas research internship focused on “Quantifying the Socio-Economic Impacts of Electric Vehicle (EV) Charging Stations on Local Commerce.” The internship took place at the Center for Urban Science and Progress (CUSP), New York University, from June 26, 2024, to September 26, 2024. During this period, Mavin De Silva had the opportunity to work under the guidance of Professor Takahiro Yabe, an expert in Causal Inference techniques. Professor Yabe’s research focuses on developing tools and models for analyzing large-scale human behavior data to understand collective social dynamics during disruptions and enhance the resilience of communities and cities to urban shocks such as disasters, pandemics, and disruptive technologies. Under his mentorship, Mavin De Silva employed Causal Inference techniques, particularly Difference in Difference (DiD) and Regression Discontinuity Design (RDD), to evaluate the economic impact of EV charging stations on local businesses. The research at CUSP, known for its emphasis on urban science and data-driven approaches, aligned with Mavin’s research goals. Leveraging the center’s advanced expertise and resources significantly contributed to the progression of Mavin’s research.
概要
卓越大学院プログラムGD3年マヴィン・デ・シルヴァさん(中山研)が「電気自動車(EV)の充電ステーションが地域商業に与える社会経済的影響の定量化」というテーマで海外リサーチインターンシップを実施しました。
卓越大学院プログラムGD3年マヴィン・デ・シルヴァさん(中山研)がニューヨーク大学(アメリカ、ニューヨーク)の都市科学研究センター(CUSP)にて2024年6月21日から9月28日までの約3カ月間、海外リサーチインターンシップを実施しました。この期間中、マヴィンさんは因果推論技術の専門家である矢部貴大助教授の指導のもとで研究する機会を得ました。矢部助教授の研究は大規模な人間行動データを分析するツールやモデルを開発することで、混乱時の集団的な社会ダイナミクスを理解し、災害やパンデミック、破壊的技術などの都市ショックに対するコミュニティや都市の回復力を高めることにあります。矢部助教授の指導のもと、マヴィンさんは因果推論の手法、特に差分推論(DiD)と回帰不連続設計(RDD)を用いて、EV充電ステーションが地元企業に与える経済的影響を評価しました。都市科学とデータ駆動型アプローチを重視することで知られるCUSPでの研究はマヴィンさんの研究目標と合致しており、同センターの高度な専門知識とリソースの活用はマヴィンさんの研究の進展に大きく貢献しました。
![]() Presenting at RUN Lab Meeting |
![]() Receiving a Congratulatory Note from Prof. Yabe |
更新日:2024年10月16日
卓越大学院プログラムGD3年Daoさん(山口研)が、「ラテックスゴムの廃水処理に関する研究」というテーマで海外発展リサーチインターンシップを実施しました
卓越大学院プログラムGD3年NGUYEN PHAM HONG DAOさん(幡本研、カントー大学出身、ベトナム)が、2024年8月5日から9月20日までの約1か月半、ベトナムのホーチミン市科学大学において、「ラテックスゴムの廃水処理に関する研究」というテーマで海外発展リサーチインターンシップを実施しました。ベトナムの天然ゴム製品の包括的な炭素プロファイルをベトナムの南部、北部、中部高原で調査しました。この研究の目的は、ベトナムで生産されるゴム1トンにつきどれだけの温室効果ガスが排出されるかを計算することです。これらのデータから、山口研の廃水処理システムを含む適切な解決策を提案する予定です。
![]() ベトナム各地のゴム工場を訪問 |
![]() ホーチミン科学大の学生とサンプルを収集・分析 |
更新日:2024年10月16日
卓越大学院プログラムGD5年安原雅貴さん(南部研)が、「筋電位を用いたインターフェースの探索」というテーマで海外発展リサーチインターンシップを実施しました
卓越大学院プログラムGD5年安原雅貴さん(南部研、長岡高専出身)が、2024年9月17日から10月10日までの約3週間、イギリスのインペリアルカレッジロンドンにおいて「筋電位を用いたインターフェースの探索」というテーマで海外発展リサーチインターンシップを行いました。最先端の身体拡張インターフェースについて議論を行うことができ、貴重な経験となりました。
|
開発した筋電位測定インターフェースを試している様子 |
更新日:2024年8月6日
卓越大学院プログラムGD2年池内丈人さん(伊東研)が、「パワーエレクトロニクス機器の設計開発および評価」というテーマでプロジェクトリーダー実習を実施しました
卓越大学院プログラムGD2年池内丈人さん(伊東研、神戸高専出身)が、ポニー電機株式会社横浜事業所にて「パワーエレクトロニクス機器の設計開発および評価」というテーマで2024年5月6日から7月9日の約2ヶ月間のプロジェクトリーダー実習を行いました。 本プロジェクトではAC/DC変換を行うマルチポート変換器について検討を行いました。本研究の進展により、電気自動車の充放電をより高効率に行えます。
|
実験装置の例 |
更新日:2024年7月17日
卓越大学院プログラムD2の坂口穂貴さん(石橋研)が国際学会「Magnetics and Optics Research International Symposium (MORIS)」と「International Conference on Magnetism (ICM)」に参加し、学会発表を行いました。
卓越大学院プログラムD2の坂口穂貴さん(石橋研、奈良高専出身)が2024年5月28日-31日にイギリスのヨークで開催された「Magnetics and Optics Research International Symposium (MORIS)」と2024年6月30日-7月5日にイタリアのボローニャで開催された「International Conference on Magnetism (ICM)」に参加し、自身の研究成果の発表や活発な議論を行いました。
![]() MORISでの口頭発表の様子 |
![]() ICMでのポスター発表の様子 |
更新日:2024年7月17日
卓越大学院プログラムD2の坂口穂貴さん(石橋研)が「酸化物磁性体の光学・磁気光学特性に関する研究」というテーマで海外発展リサーチインターンシップを実施しました
卓越大学院プログラムD2の坂口穂貴さん(石橋研、奈良高専出身)が2024年6月3日~28日にカレル大学(プラハ、チェコ)において、「酸化物磁性体の光学・磁気光学特性に関する研究」というテーマで海外発展リサーチインターンシップを実施しました。所属研究室で作製した酸化物磁性体を持ち込み、その光学特性や磁気光学特性を調べるために、測定および解析方法を学びながら実習に取り組みました。
![]() 低温磁気光学Kerrスペクトルの実験装置 |
![]() 培養試験の様子 |
更新日:2024年7月2日
卓越大学院プログラムGD5年田中太一さん(南部研)が、「視覚と聴覚に頼らない触覚振動フィードバックによる筋電制御義手の操作性の向上」というテーマで海外発展リサーチインターンシップを実施しました
卓越大学院プログラムGD5年田中太一さん(南部研、宇部高専出身)が、イギリスのインペリアルカレッジロンドンのEtienne Burdet 教授の下、2024年4月5日から6月14日の約2ヶ月間の海外発展リサーチインターンシップを行いました。 このインターンシップでは、高性能ながらユーザにとって扱いにくいと評価されている筋電制御義手の操作性を改善する研究に取り組みました。具体的には、義手の動作速度を振動としてユーザにフィードバックすることで、操作性を向上させる方法を研究しました。この経験を通して、対照群と有意差が出るようにタスクを設定する難しさを学びました。実操作を想定した丁度良い難易度のタスクを設定することの重要性と難しさを深く理解することができ、非常に貴重な学びとなりました。
|
作成した実験システム |
更新日:2024年7月2日
卓越大学院プログラムGD4年末満堅人さん(南部研)が、「人間-ロボットの触覚コミュニケーションにおける神経メカニズムの解析を目指して」というテーマで海外発展リサーチインターンシップを実施しました
卓越大学院プログラムGD4年末満堅人さん(南部研、都城工業高専出身)が、イギリスのインペリアルカレッジロンドン において、2024年4月7日から6月14日の約2ヶ月間の海外発展リサーチインターンシップを行いました。在外先研究室は人間のような運動を行う機械を作成し、人間-機械を触覚バンドし、相互的な触覚情報交換が行われる実験環境を構築した、この状況下における脳活動を調査することで、人間が機械の運動情報を統合-調和させる神経メカニズムの解明を目指しました。このような最先端の環境における研究活動は自身の研究生活を見直す良い機会となりました。
|
触覚コミュニケーションのデモ実験の様子 |
更新日:2024年7月2日
卓越大学院プログラムGD4年遠藤浩毅さん(髙橋(勉)研)が、「棒状粒子懸濁液における低ワイゼンベルグ数流れ場での粒子配向挙動の解析」というテーマで海外リサーチインターンシップを実施しました
卓越大学院プログラムGD4年遠藤浩毅さん(髙橋(勉)研、仙台高専、名取キャンパス出身)が、フランスの南ブルターニュ大学ロリアンキャンパス、DUPUY DE LÔME RESEARCH INSTITUTE にて2023年10月1日から2024年2月22日の約5か月間の海外リサーチインターンシップを行いました。こちらの研究ユニットでは主に複合材料が大きなテーマとなっており、アカデミックな研究のほかに、外部研究機関と現地企業と共同で新たな複合材料の開発を遂行されています。本プロジェクトでは、よわい粘弾性液体中に存在する棒状粒子がせん断流動により粒子配向する挙動をマクロ的な視点でモデル化し、数値シミュレーションに解析検討を行いました。この研究の発展として、広範な粘弾性領域における粒子の配向挙動を解明し、粒子複合材料に関する新たな知見を得られることが期待されています。
|
教授方との写真(左 Prof. Gilles Ausias、右 Prof. Julien Ferec、中央 GD4遠藤) |
更新日:2024年4月3日
卓越大学院プログラムGD3年永井麻実さん(山口研)が「タイにおけるエビの閉鎖型陸上養殖排水処理技術の研究」というテーマで海外リサーチインターンシップを実施しました
卓越大学院プログラムGD3年永井麻実さん(山口研、京都府立大出身)が、2023年12月4日~2024年2月9日の約2カ月間、チュラロンコン大学(バンコク、タイ)において、「タイにおけるエビの閉鎖型陸上養殖排水処理技術の研究」というテーマで海外リサーチインターンシップを実施しました。我々の研究グループでは閉鎖循環型陸上養殖に応用できる循環型窒素除去システムを開発していますが、チュラロンコン大学においてもこのシステムについて高い知識を持ち、かつシステムの構築スキルも盛んです。本インターンシッププログラムでは、実際にエビを養殖した実養殖水を用いた連続実験を実施し、養殖排水システムの性能について評価しました。
![]() サンプリングの様子 |
![]() 培養試験の様子 |
更新日:2024年3月28日
卓越大学院プログラムGD3年土田脩斗さん(山田研)が、「火災リスク低減に向けたハイブリッド太陽電池アレイの最適設計」というテーマで海外発展リサーチインターンシップを実施しました
卓越大学院プログラムGD3年土田脩斗さん(山田研、長岡高専出身)が、イギリスのKing’s College London にて、2024年1月~3月中の約2ヶ月間、海外発展リサーチインターンシップを行いました。 本プロジェクトでは、一般的な太陽光パネルと表面と裏面で発電可能な両面受光太陽光パネルの組み合わせたハイブリッド太陽光発電システムによって、高い発電量と火災のリスク低減とを両立させる手法について研究しました。 本実習で滞在した研究室と私が所属している研究室との運営形態には大きな違いがありました。本実習で、この違いを経験したことは、研究の進め方について深く考え直す機会となりました。今後は、両者の長所を組み合わせ、より効果的に研究を進めていきたいと考えています。
|
Yihua Hu 博士との写真 |
更新日:2024年3月15日
卓越大学院プログラムGD5 大畠慶太さん(伊東研)が「多変量解析に基づくSolid-State Transformerの回路トポロジーの探求」というテーマで海外リサーチインターンシップを実施しました
卓越大学院プログラムGD5大畠慶太さん(伊東研,茨城高専出身)が,スイス連邦工科大学チューリッヒ校 Power Electronic Systems Laboratory にて2023年12月~2月に2.5カ月間の海外リサーチインターンシップを行いました。 本プロジェクトではAC/DC変換を行う電力変換器Solid-State Transformer (SST)のいくつかの回路構成について検討を行いました。本研究の進展により,太陽光発電などの再生可能エネルギーの活用および電気自動車の充放電をより高効率に行えます。
|
回路シミュレーション例 |
更新日:2024年2月29日
2024/2/9(金)ICT実務演習の最終報告会を実施しました
卓越大学院プログラムでは、全学生が最先端の実戦レベルでのICTスキルを身につけることを義務付けています。受講生のほとんどは、情報工学が専門ではないものの、AIサービスを短期間で実装できる「敏捷性」を身につけることが出来ました。最終報告会では、株式会社クレスコ(https://www.cresco.co.jp/)の井上祐寛様より各発表を講評いただくとともに、デジタル変革をリードするIT企業における生成AIの活用事例を講演いただきました。
【受講生の感想例(一部編集)】
・様々な最先端のユースケースから、AIがICTにどのように活用できるかを学ぶことができた。
・研究活動等で生成AIは使用していたものの、論文ベースの効果的な活用方法の知見はなかった。この知見は今後の研究活動の生産性を高めるにつながるため、有意義であった。
・クラウドサービスを⽤いて⾝近な課題を解決するモデルの開発を⾏うことや、実習の前後でAIの活⽤例についてお話しを伺うことで、ITへの敷居が下がったように感じる。これにより、課題解決の⼿段としてIT技術の活⽤をより⾝近に⽇常的に考えることができ、より柔軟で多様なアイデア創出が可能となった。
・⾼度なシステムを開発するにはプログラミング技術の習得などが必要であるが、ITの専⾨知識を持つ技術者に的確な発注ができるといった恩恵を得ることができた。
![]() |
![]() |
更新日:2024年2月19日
卓越大学院プログラムGD5 山口正通さん(伊東研)が「パワー半導体デバイスの信頼性向上に関する研究」テーマで海外リサーチインターンシップを実施しました
卓越大学院プログラムGD5山口正通さん(伊東研, 都立産技高専品川キャンパス出身)が,韓国のAjou University Power Electronics Laboratory にて2カ月間の海外リサーチインターンシップを行いました。実習先の研究室には博士課程の学生も多く在籍し,研究室のKyo-Beum Lee 教授はIEEEや韓国電気学会のパワーエレクトロニクス分野で幅広くご活躍される教授の一人です。学生や教授との議論を通して,電力変換回路に欠かせないパワー半導体デバイスの信頼性向上に関する新たな手法の基礎検討に取り組みました。
![]() |
![]() |
![]() |
更新日:2023年2月6日
卓越大学院プログラムGD4年安原雅貴さん(南部研)が、「脳波を用いたインターフェースの探索」というテーマで海外リサーチインターンシップを実施しました
卓越大学院プログラムGD4年安原雅貴さん(南部研、長岡高専出身)が、イギリスのインペリアルカレッジロンドンにおいて2023年9月9日~2023年12月19日の約3ヶ月間、「脳波を用いたインターフェースの探索」というテーマで海外リサーチインターンシップを行いました。 とても国際色豊かな研究室で、フランス出身、スペイン出身、タイ出身、中国出身など多様性あふれる先生、ポスドク、学生たちに囲まれながら研究や議論をすることができ、貴重な経験となりました。
|
Etienne Burdet先生との写真 |
更新日:2023年2月6日
卓越大学院プログラムGD4年田中太一さん(南部研)が、「触覚振動と音フィードバックによる筋電制御義手の操作性の向上」というテーマで海外リサーチインターンシップを実施しました
卓越大学院プログラムGD4年田中太一さん(南部研、宇部高専出身)が、mperial College LondonのEtienne Burdet 教授の元、2023年9月9日~2023年12月19日の約3ヶ月間、「触覚振動と音フィードバックによる筋電制御義手の操作性の向上」という研究テーマで海外リサーチインターンシップを行いました。このインターンシップでは、高性能ながらユーザにとって扱いにくいと評価されている筋電制御義手の操作性を改善する研究に取り組みました。具体的には、義手の動作速度を振動や音としてユーザにフィードバックすることで、操作性を向上させる方法を研究しました。この経験を通して、ヒトと機械の両方の特性とシステムの要件を満たしながら、理想的に機能するシステムを開発することの難しさを深く理解することができ、非常に貴重な学びとなりました。
|
Etienne Burdet教授との記念撮影 |
更新日:2023年2月5日
卓越大学院プログラムGD3年末満堅人さん(南部研、都城高専出身)が、「人間-ロボットの触覚コミュニケーションにおける神経メカニズムの解明を目指して」というテーマで海外リサーチインターンシップを実施しました
卓越大学院プログラムGD3年末満堅人さん(南部研、都城高専出身)が、2023年9月10日~2023年12月19日の約3カ月間、 Imperial College London(イギリス)において、「人間-ロボットの触覚コミュニケーションにおける神経メカニズムの解明を目指して」というテーマで海外リサーチインターンシップを実施しました。子供が歩けるようになるのを手助けする親のような, 二者間の身体的な結合によって相互に行われる情報交換は人間の運動上達に関わり重要です。在外先研究室は人間のような運動を行う機械を作成し, 人間-機械を触覚バンドし, 相互的な情報交換が行われる実験環境を構築しました。この状況下における脳活動を調査することで、人間が機械の運動情報を統合-調和させる神経メカニズムの解明することを目指しました. このような最先端の環境における研究活動は自身の研究生活を見直す良い機会となりました。
|
Etienne Burdet 教授(左) との写真 |
更新日:2024年2月2日
卓越大学院プログラムGD4年片岡翔太郎さんが新潟版未踏的人材育成事業ETSUZANでPMを担当した2プロジェクトがそれぞれ起業・クラウドファンディング目標達成をしました。
卓越大学院プログラムの知識システム研究室GD4年片岡翔太郎さん(高知高専出身)が、2023年度新潟版未踏的人材育成事業ETSUZANのプロジェクトマネージャー(PM)の1人として新潟県内の若手クリエータの発掘・育成に取り組みました。2023年9月から2024年1月までの約5ヶ月間、チームnexfare(長岡高専生3名、長岡造形大生2名)とチームWeareable(長岡高専生3名)のPMとして伴走的な支援を行い、成果報告会を2024年1月14日(日)にNINNOにて実施しました。期間内にチームnexfareは提案テーマの事業化を目指して起業し、チームWeareableは開発したウェアラブル楽器”Synthevery”の製品化に向けてクラウドファンディングを開始しました。同クラウドファンディングは2024年1月12日に開始後、わずか3日間で目標金額100%を達成し、現在はネクストゴールに向けて新たな企画に取り組んでいます。
クラウドファンディングキャンペーンページ:https://igg.me/at/synthevery
(当該クラウドファンディングキャンペーンは2024年3月12日をもって終了します。)
|
成果報告会の様子
|
【新潟版未踏的人材育成事業ETSUZANとは】
経済産業省令和4年度未踏的な地方の若手人材発掘育成支援事業補助金「AKATSUKIプロジェクト」の採択を受け、新潟を対象に実施されるIT人材発掘・育成プログラム。ETSUZAN=越山。夢中になって開発に取り組める環境は地方に少なく、経験格差が起こっています。この格差を新潟から解消し、ITに関する知識やスキルを有し新しい技術やサービスを生み出すクリエータを発掘し育成するプログラムです。
プログラムホームページ:https://etsuzan.org
【チームnexfareについて】
採択テーマ:介護業界のDX化を促進しつつ、「買い物体験」を通して介護施設をより能動的で楽しい環境へと変化させられるハイブリッドストアサービス「Airshop」を開発します。
メンバー:
・山口 友也さん(長岡高専 電子機械システム工学専攻 2年)
・樋口 剛琉さん(長岡高専 機械工学科 5年)
・眞鍋 友海さん(長岡造形大学 視覚デザイン学科 2年)
・渡邉 未夏さん(長岡造形大学 視覚デザイン学科 2年)
・金井 京平さん(長岡高専 電子機械システム工学専攻 1年)
|
|
プロジェクト期間中の活動:
介護施設の入居者に日常の買い物体験を届けるために、ICカードを用いたスマート売店システムの開発を行いました。協力していただいている介護施設での実証実験を通して、入居者や介護職員の方からの意見を参考にしながら着実にプロダクト開発に取り組みました。本チームは2024年1月16日に株式会社nexfareを設立し、ETSUZAN終了後も継続的にサービス開発に取り組んでいきます。
成果報告会での発表の様子(Youtube)
また、nexfareは2024年2月4日に開催されたリーンローンチパッド全国大会(http://startupbrain.jp/?page_id=454)に出場し、審査員賞を受賞しました。全国各地で開催されたリーンローンチパッドの最優秀チームが参加する全国大会において優秀な成績を残すことができました。
|
成果報告会の様子
|
【チームWeareableについて】
採択テーマ:日常生活の動作に連動して音楽や効果音を鳴らすウェアラブルデバイスを開発し、人類の日常を少しだけ楽しくすることを目指します。
メンバー:
・渡辺麟さん(長岡高専 電子機械システム工学専攻 2年)
・島田佳祐さん(長岡高専 機械工学科 5年)
・藤本清太郎さん(長岡高専 機械工学科 5年)
|
|
プロジェクト期間中の活動:
特定の”動き”に連動してそれに合った音を鳴らす独自のウェアラブルデバイスと専用ソフトウェアを開発しました。これを用いてスポーツチームを応援するウェアラブルデバイスや、日常に音楽を融合するウェアラブル楽器”Synthevery”を開発しました。Syntheveryは2024年1月12日(金)に米国クラウドファンディングサービス Indiegogoにてリリースし、わずか3日間で目標達成率100%を達成しました。ETSUZAN終了後もプロダクト販売に向けて開発を続けています。
成果報告会での発表の様子(Youtube)
—
【片岡翔太郎さんのプロフィール】
高知高専出身。卓越大学院プログラムGD4年。2019年には未踏AIフロンティアプログラムに採択され、工場内の作業動画解析に関する研究に尽力。成果が認められ経産省からAIフロンティアパスファインダーとしての認定を受ける。2021年には大学での研究を社会実装し、人類とAIの共働による持続的な産業革新を目指すために当時の研究室指導教員らと共に株式会社マヨラボを設立した。現CEOを務める。 マヨラボは新潟県スタートアップ・アイディア活用プロジェクト及び長岡市スタートアップ創出補助金の支援を受けながらAIを利用した企業リスク情報収集システム/特許解析システム/車載カメラ画像解析システムの共同研究開発などを大学や企業と連携し実施している。
更新日:2024年1月26日
Laddu Samadhi Wandana, a second-year student in the WISE Program (GD2), is currently engaged in an overseas research internship program in Thailand.
As a GD2 student, Mrs. Samadhi Wandana has been actively participating in the overseas research internship, spanning approximately one month from December 4, 2023, to January 4, 2024. This program is taking place at the laboratory of Prof. Dr. Wiboonluk Pungrasmi, specifically at the Aquaculture Feed Technology Lab within the Center of Excellence for Marine Biotechnology at Chulalongkorn University in Bangkok, Thailand. The focus of Mrs. Wandana’s research is on the “Development of a Simultaneous N and SS Removal System Combining DHS-USB and BFT.” The laboratory, already involved in biofloc technology, aligns with her research objectives as she concentrates on biofloc formation. Leveraging the lab’s experience and expertise in biofloc technology will significantly contribute to the advancement of her research.
卓越プログラム生GD2年LADDU SAMADHI WANDANAさん(山口研)がDHS-USBとBFTを組み合わせた窒素とSSの同時消去システムの開発のため海外リサーチインターンシップを実施しました。
卓越大学院プログラムGD2年LADDU SAMADHI WANDAVAさん(山口研、スリランカ・スリジャヤワルダナプラ大学出身)がチュランコロン大学(タイ、バンコク)の海洋バイオテクノロジー研究センター内の養殖飼料研究室にて2023年12月4日から2024年1月4日までの約1か月間、海外リサーチインターンシップを実施しました。すでに、バイオフロフロック技術には携わっているこの研究所は、私の研究目的に合致していました。バイオフロック技術における研究室の経験と専門知識を活用することは、私の研究目標に貢献すると思いました。
![]() Picture of the aquaculture feed lab, where I conducted my work |
![]() Conducting laboratory experiments & sampling① |
![]() Conducting laboratory experiments & sampling② |
![]() Biofloc present in Imhoff cone |
更新日:2024年1月26日
卓越大学院プログラムGD3年土田脩斗さん(山田研)が、「深宇宙環境における集光型太陽電池の優位性の検証」というテーマでプロジェクトリーダー実習を実施しました
卓越大学院プログラムGD3年土田脩斗さん(山田研、長岡高専出身)が、国立研究開発法人宇宙航空研究開発機構 筑波宇宙センター(茨城県つくば市)にて、2023年11月~12月の2ヶ月間、プロジェクトリーダー実習を行いました。本プロジェクトでは、極低温・低日射照度(LILT)条件における太陽電池の劣化を、太陽光の集光によって抑制する効果を実験によって検証しました。今後は、今回の実験結果を踏まえて、最適な集光型太陽電池の構造を探求します。
![]() 実験の様子① |
![]() 実験の様子② |
更新日:2024年1月26日
卓越大学院プログラム GD3年永井麻実さん(山口研)が「長岡未来デザインコンテスト2023」にてグランプリを受賞しました
2023年12月10日、GD3年永井麻実さん(山口研、京都府立大出身)が「長岡未来デザインコンテスト2023」でグランプリを受賞しました。 このコンテストは、長岡市の課題解決を目指す産学官連携の取り組みであり、今大会では電子商取引ECサイトで実際に販売する商品の企画から地元企業4社との商談・HP作成までをおよそ4ヶ月間通して3人1チームで実施し、グランプリを獲得しました。また、賞金として20万楽天ポイントが授与されました。 グランプリを受賞した商品は、楽天市場長岡市公式ショップ「丸ごと長岡」にて商品化され、どなたでも購入可能です。(※2024年1月23日現在)
楽天HP:https://item.rakuten.co.jp/nagaokashi/c/0000000140/
![]() 大会集合写真 |
![]() グランプリ受賞商品 |
更新日:2024年1月26日
環境社会基盤系 渡利助教、技術科学イノベーション系 ヌル・アデリン助教、機械系 滝本助教、GD3永井さん、GD2原田さん(以上、山口研)、MARTINEZ SANCHEZ ALEJANDRO ISIDROさん(中山研)が国際会議「ICETI 2023 – International Conference on Environmental Technology and Innovation 2023」に参加し学会発表を行いました
2023年11月29日、環境社会基盤系 渡利助教、技術科学イノベーション系 ヌル・アデリン助教、機械系 滝本助教、GD3永井麻実さん(山口研、京都府立大出身)、GD2原田隆大さん(山口研、鹿児島高専出身)、MARTINEZ SANCHEZ ALEJANDRO ISIDROさん(中山研、メキシコ・モンテレイ大学出身)が、ベトナム·ホーチミン Ton Duc Thang大学で開催されたInternational Conference on Environmental Technology and Innovationに参加し口頭発表を行いました。様々な国から多くの研究者が参加し新たなネットワークを構築することができました。
![]() 集合写真 |
![]() 発表の様子 |
更新日:2023年1月11日
国際ジャーナルAdvanced Composites and Hybrid Materials に、卓越大学院プログラムGD4年Zhiming SHENさん(中山研)らの論文が掲載されました
2023年12月10日、技術科学イノベーション専攻 中山忠親 教授、卓越大学院プログラムGD4年Zhiming SHENさん(中国出身)らの論文「Fabrication of H-shaped structure magnetorheological elastomer film for enhancing electrical properties by AC electric field」がAdvanced Composites and Hybrid Materials (IF:20.1)に掲載されました。
更新日:2023年1月11日
卓越大学院プログラムGD4年沈志明(中山研)、他3名が大学院教育改革フォーラム 2023に参加しました
令和5年12月1日~2日につくばで行われた、大学院教育改革フォーラム 2023に卓越大学院プログラムGD4年沈志明(中山研)、他3名が参加しました。このフォーラムには全国の卓越⼤学院プログラムより、長岡技大「グローバル超実践ルートテクノロジープログラム」の学生を含める22プログラムの学⽣が参加しました。このイベントは大学院生向け研究発表のポスターセッションとワークショップを開催されました。長岡技大4名がイベントに参加し、研究交流、レゴを用いたアイデア出しを行いました。様々なバックグラウンドの参加者がいたため、多様な分野の研究情報や各大学の状況等の共有、各自の専門性に基づいたアイデア出しや意見交換を行うことができました。参加者から「非常に有意義なワークショップだった。」「他の卓越大学院の学生とも交流したい。」などの意見をいただくことができました。 12月2日にワークショップでGD4沈 志明さんのグループは、【Creation of opportunities for interaction throughout the WISE program】をテーマとして、発表し学際賞を受賞しました。
|
写真は学際賞を受賞したグループメンバー |
更新日:2023年12月8日
環境社会基盤工学系 渡利助教、技術科学イノベーション専攻GD5三輪徹さんがデルフト工科大学(オランダ)、アントワープ大学(ベルギー)、モンドラゴン大学(スペイン)を訪問しました
環境社会基盤工学系 渡利助教、技術科学イノベーション専攻 GD5三輪徹さん(山口研、豊田高専出身)が2023年11月12~19日、研究連携先であるデルフト工科大学(オランダ)、アントワープ大学(ベルギー)、モンドラゴン大学(スペイン)へ訪問しました。排水処理の世界的権威であるVan Lier 教授(デルフト工科大学)やJan Dries准教授(アントワープ大学)と、排水処理や廃棄物処理に関する最先端の知見を共有しました。また、モンドラゴン大学では互いの研究紹介やディスカッションを行い、将来的なコラボレーションについて協議しました。今回の訪問で得た知見やディスカッションを今後の研究活動に活かしていきたいと思います。
![]() ディスカッションの様子① |
![]() ディスカッションの様子② |
更新日:2023年12月5日
卓越大学院プログラムM2石井夢月さん(湯川研)が映像検索に関するワークショップであるTRECVIDのシステム開発のため海外リサーチインターンシップを実施しました
卓越大学院プログラムM2石井夢月さん(湯川研、長岡高校出身)が映像検索に関するワークショップであるTRECVIDのシステム開発のため、アメリカの国立標準技術研究所において10月上旬から約2か月間海外リサーチインターンシップを実施しました。 派遣先のNISTが主催する映像検索に関するワークショップであるTRECVIDにて用いられるテストデータセットを自動拡張するシステムの開発に携わりました。現地では派遣先担当者に限らず、世界中から集められた他のインターン生とも交流することができました。交流を通じて、同年代の彼らが国を超えた活躍を目指して自身の研究成果を全力で追うストイックな姿に衝撃を覚えたと同時に、彼らの多様な視野と経験談は将来のキャリアについて考える契機となりました。
|
TRECVID2023にてDr. Awadと |
更新日:2023年12月5日
卓越大学院プログラムM1 井澤幸広さん(庄司研)が「DNAナノポアの細胞死誘導活性の評価」というテーマでプロジェクトリーダー実習を行いました
卓越大学院プログラム 修士1年 井澤幸広さん(庄司研、群馬高専出身)が埼玉県和光市の理化学研究所において8月下旬から約2か月間、「DNAナノポアの細胞死誘導活性の評価」というテーマでプロジェクトリーダー実習を行いました。 今回の実習では、細胞培養やアッセイの研修を行い、細胞膜に細孔を構築することが期待されているDNAナノポアの細胞死誘導活性を評価しました。 細胞の取り扱いや評価手法等の技術的な内容に加え、効率的に研究を進めるための考え方やキャリア形成についても学ぶことができ多くの刺激を受けました。本実習の経験や成果は、今後の研究を加速させるのみならず、キャリア形成やプロジェクト推進力の糧となることを確信しています。
|
DNAナノポア(緑)が細胞(白矢印)の細胞膜に付着している様子 |
更新日:2023年12月5日
卓越大学院プログラムGD2年NGUYEN PHAM HONG DAOさん(山口研)が、ラテックスゴムの廃水処理に関する研究のため、ベトナムでのインターンシップに参加しました
卓越大学院プログラムGD2年 NGUYEN PHAM HONG DAOさん(山口研、カントー大学出身)が、ハノイ科学技術大学にて8月上旬から約2ヶ月間、ラテックスゴムの廃水処理に関する研究のため、海外リサーチインターンシップを行いました。ベトナム南部のゴム工場を調査し、ベトナムのゴム事情に関する最新データを収集し、ハノイ科学技術大学ではゴム廃水処理システムの模擬分析を行いました。 インターンシップと研究の成果はChemosphere誌に掲載されました。
![]() ラボのリアクターで分析するGHG排出ガス |
![]() ゴム工場でのGHG排出ガスサンプリング |
更新日:2023年11月9日
インド水文学研究所Vinay Kumar Tyagi先生を招待して講座を行いました。
2023年11月7日、環境社会基盤系 渡利助教がインド水文学研究所のVinay Kumar Tyagi先生を招待し、博士学生を対象とした論文講座を企画・開催いたしました。卓越大学院プログラム生は、GD5年三輪徹さん(豊田高専出身、オンライン参加)、GD3年永井麻実さん(京都府立大学出身)、D1年根津拓福さん(長岡高専出身)、山田光陽さん(松江高専出身)、GD2年LADDU SAMADHI WANDANAさん、GD1年永妻志問さん(松江高専出身)(以上、山口研)が参加し、各々の研究への意欲をより一層高めました。
![]() 集合写真 |
![]() 講座の様子 |
更新日:2023年10月13日
環境社会基盤系 渡利助教、山口研GD5三輪徹さん、GD3永井麻実さん、GD1永妻志問さん、D1根津拓福さん、山田光陽さんが国際会議「第3回国際水環境シンポジウム The 3rd international symposium on Water Environment for Young researchers’ Network (WEYN)」の企画及び運営を行いました
環境社会基盤系 渡利助教、山口研GD5三輪徹さん(豊田高専出身)、GD3永井麻実さん(京都府立大学出身)、GD1永妻志問さん(松江高専出身)、D1根津拓福さん(長岡高専出身)、山田光陽さん(松江高専出身)が国際会議「第3回国際水環境シンポジウム The 3rd international symposium on Water Environment for Young researchers’ Network (WEYN)」の企画及び運営を行い、2023年9月8日に愛知高原国定公園旭高原元気村で開催しました。 当日は37名の学生及び教員が参加し、研究成果の発表や活発なディスカッションを行いました。
![]() 集合写真 |
![]() 発表の様子 |
更新日:2023年8月1日
環境社会基盤工学系及び技術科学イノベーション系 山口隆司教授、環境社会基盤工学系 渡利高大 助教、卓越大学院プログラムGD5年三輪徹(山口研)、技術科学イノベーション専攻GD5年Huongさんが「1st AEET workshop, held in Ghent University Global Campus, Incheon, ROK 2023」に参加しました
環境社会基盤工学系及び技術科学イノベーション系 山口隆司教授、環境社会基盤工学系 渡利高大 助教、卓越大学院プログラムGD5年三輪徹さん(山口研・豊田高専出身)、技術科学イノベーション専攻GD5年Huongさんが韓国のGhent University Global Campus にて開催された「1st AEET workshop, held in Ghent University Global Campus, Incheon, ROK 2023」に参加し、互いの研究を紹介し及び今後の協働体制について議論しました。
![]() ディスカッションの様子 |
![]() 集合写真 |
更新日:2023年8月1日
国際ジャーナルChemical Engineering Journal に、卓越大学院プログラムGD5年三輪徹(山口研)さんらの論文が掲載されました
2023年7月17日、環境社会基盤工学専攻 山口隆司 教授、幡本将史 准教授、渡利助教授、卓越大学院プログラムGD5年三輪徹さん(山口研・豊田高専出身)らの論文「Sewage-derived substances and dead microbial cells cause gel biofilm formation in membrane bioreactors treating real sewage」がChemical Engineering Journal (IF:16.744)に掲載されました。
更新日:2023年8月1日
卓越大学院プログラムGD4年片岡翔太郎さん(湯川研)が新潟版未踏的人材育成事業”ETSUZAN”(経済産業省助成、長岡市・新潟市・新潟県後援)のPMとして選定されました
卓越大学院プログラムGD4年片岡翔太郎さん(湯川研、高知高専出身)が、2023年度実施の新潟版未踏的人材育成事業”ETSUZAN”のプロジェクトマネージャーの1人として新潟県内の若手クリエータの発掘・育成に取り組みます。片岡翔太郎さんは2019年度未踏AIフロンティアプログラムにおいて育成対象者として採択され、メンターの支援のもとで研究開発に従事しました。今回は自身がPMとして支援する側となり、情熱あふれる未来のクリエータを育むために伴走的な育成活動を行います。
【新潟版未踏的人材育成事業”ETSUZAN”とは】
プログラムの概要:
経済産業省令和4年度未踏的な地方の若手人材発掘育成支援事業補助金「AKATSUKIプロジェクト」の採択を受け、新潟を対象に実施されるIT人材発掘・育成プログラム。 ETSUZAN=越山。夢中になって開発に取り組める環境は地方に少なく、経験格差が起こっています。この格差を新潟から解消し、ITに関する知識やスキルを有し新しい技術やサービスを生み出すクリエータを発掘し育成するプログラムです。
特徴:
・ビジコンではなく、一つに秀でた変人を育成すること。
・優等生でプレゼンが上手い人<内に秘めた熱意とやり遂げる力がある人を評価する。
・審査はPM(プロジェクトマネージャー)の独断と偏見で行い、PMが育成したい人材を選び、伴走する。
・開発期間を通し、一つのプロダクト・サービスを作り上げることをゴールとします。
スケジュール:
※クリエータ育成期間 2023年9月1日〜2024年1月14日
※スケジュール・内容が変更になる可能性があります。
PM(プロジェクトマネージャー):
クリエータ募集:
(1)対象
15歳(高校生以上)〜30歳(2023年4月1日時点)
新潟県在住・在勤・在学者
原則、全てのプログラムに参加できる人
(2)募集人数
5チーム(1チーム1〜3名)
(3)求める人材
作り上げたいプロダクト(ソフト・ハード問わず)のアイデアと、熱意がある人
※アイデアの構築と応募書類の作成まで募集イベントでサポートいたします。
(4)採択後のメリット
・開発時間に対し、時給が発生(最大報酬は実施期間全体で1チーム100万円)
・PMとの月に1〜2回のメンタリング、事務局・メンターとのメンタリングでサポート
・新潟の起業家コミュニティに接する機会
(5)応募方法
募集イベント参加 ※参加は任意
↓
応募フォーム送信
↓
一次審査
↓
二次審査 ※プレゼン及び面談
↓
決定 ※応募締め切りから1〜2週間で決定予定
(6)応募書類
下記の応募フォームよりご応募お願いいたします。
▼クリエータ応募フォーム
https://forms.gle/MkQUVSvx6zQRvooD8
事務局/運営:
・株式会社イードア
・Socialups株式会社
・株式会社ウィズグループ
・株式会社KOIYAL
・株式会社ビアパイント
後援:
・長岡市、新潟市
プログラムホームページ:https://etsuzan.org
—
【片岡翔太郎さんのプロフィール】
高知高専出身。卓越大学院プログラムGD4年。2019年には未踏AIフロンティアプログラムに採択され、工場内の作業動画解析に関する研究に尽力。成果が認められ経産省からAIフロンティアパスファインダーとしての認定を受ける。2021年には大学での研究を社会実装し、人類とAIの共働による持続的な産業革新を目指すために当時の研究室指導教員らと共に株式会社マヨラボを設立した。現CEOを務める。 マヨラボは新潟県スタートアップ・アイディア活用プロジェクト及び長岡市スタートアップ創出補助金の支援を受けながらAIを利用した企業リスク情報収集システム/特許解析システム/車載カメラ画像解析システムの共同研究開発などを大学や企業と連携し実施している。
更新日:2023年8月1日
卓越大学院プログラムGD3年味田渉さん(中山研)、GD2年橋本裕朔さん(宮下研)が7月4日放送回のNHK「新潟ニュース610」に出演しました
卓越大学院プログラムGD3年味田渉さん(中山研・室蘭工業大学出身)と卓越大学院プログラムGD2年橋本裕朔さん(宮下研・石川高専出身)がNHK新潟の「新潟ニュース610」に出演いたしました。 DXものづくりラボで取り組んでいる工作機械をメタバースとの連携についての取り組みが紹介されました。
詳しくは下記の記事をご覧下さい。
●NHK 「大学でメタバース」
https://www.nhk.or.jp/niigata/lreport/article/003/71/
●NHK新潟放送局 「新潟ニュース610」
放送日時:2023年7月4日 18:10~
https://www.nhk.jp/p/ts/VRP45LQK9Q/
![]() 3Dプリンター操作の撮影 |
![]() インタビュー時の写真 |
更新日:2023年7月14日
卓越大学院プログラムGD3年 豊場亮太さん(大塚研)が「3次元多孔質構造体の有限要素解析(FEM)手法の開発と干渉効果の生じる応力場評価」というテーマで海外リサーチインターンシップを行いました
卓越大学院プログラムGD3年 豊場亮太さん(大塚研、岐阜高専出身)がオーストラリアのカーティン大学において4月中旬から約2ヶ月半、「3次元多孔質構造体の有限要素解析(FEM)手法の開発と干渉効果の生じる応力場評価」というテーマで海外リサーチインターンシップを行いました。施術時に微調整が必要となる生体用インプラントのための高耐久・高延性を実現する最適構造の開発を目指しており、本インターンシップでは、最適化解析に組込み可能な有限要素解析(FEM)手法を開発し、多孔質構造を採用する最適構造の力学特性(干渉効果)を議論しました。
解析手法等の技術的な内容に加え、博士課程学生に要求される水準や論理構築の方法、キャリア形成について多角的な指導を受けられました。自分自身の未熟さと能力不足を痛感しましたが、この2ヶ月半の経験は、今後の研究活動を加速させる強力な原動力になると確信してます。
|
最終報告会の写真(左:豊場本人、右:Prof. Ian J. Davies) |
更新日:2023年7月3日
国際ジャーナルACS Nano (ACS Publications)にて、卓越大学院プログラムD1小岩滉宜さん、M1井澤幸広さんらの論文が掲載されました
2023年5月24日、ナノ・バイオインテグレーテッドシステム研究室(庄司研)卓越大学院プログラムD1小岩滉宜さん(一関高専出身)、M1井澤幸広さん(群馬高専出身)らの論文「DNA Nanopore-Tethered Gold Needle Electrodes for Channel Current Recording」が国際ジャーナルACS Nano(IF 18.027) に掲載されました。詳細はこちら
更新日:2023年7月3日
環境社会基盤系 渡利助教、技術科学イノベーション系 ヌル・アデリン助教、機械系 滝本助教、GD5三輪徹さん(山口研、豊田高専出身)が国際会議「BIORESTEC – 4th International Conference for Bioresource Technology for Bioenergy, Bioproducts & Environmental Sustainability」に参加し学会発表を行いました
環境社会基盤系 渡利助教、機械系 滝本助教、技術科学イノベーション系 ヌル・アデリン助教、GD5三輪徹さん(山口研、豊田高専出身)が2023年5月14-17日、イタリア共和国トレンティーノアルトアディジェ州リーヴァ・デル・ガルダで開催された「BIORESTEC – 4th International Conference for Bioresource Technology for Bioenergy, Bioproducts & Environmental Sustainability」に参加し、自身の研究成果を発表しました。 日本、メキシコ、ギリシャ、オランダ、イタリア、ポーランドなど様々な国々の研究者とディスカッション及び交流し、自分の研究に対して客観的な意見を聞くことによって新たな視点や着想を得ることができました。また国際的に著名な研究者とも交流したことで、とても良い刺激をいただきました。今回の学会で得た知見や経験を今後の研究に活かしていきたいと思います。
![]() 発表の様子① |
![]() 発表の様子② |
![]() 発表の様子③ |
![]() 集合写真 |
更新日:2023年4月25日
卓越大学院プログラムGD3年 齋藤祐功さん(中山研)がFM-NIIGATA「NAMARA MIX」に出演しました
卓越大学院プログラムGD3年(出演時学年)齋藤祐功さん(中山研、長岡高専出身)が、2023年3月21日(火)19:00~放送のFM-NIIGATA「NAMARA MIX」に出演しました。
内容は学生生活や現在関わっている活動について話しました。
|
パーソナリティとの集合写真 |
◎番組名:FM-NIIGATA 「NAMARA MIX」
◎日時:2023年3月21日(火)19:00~
https://www.fmniigata.com/program/493
更新日:2023年4月25日
特別ゲストを招待して座談会を開催しました
3月15日に長岡技術科学大学東京サテライトキャンパスにて、本田技研工業株式会社 専務執行役員 高橋尚男様、NEDO(国立研究開発法人 新エネルギー・産業技術総合開発機構)イノベーション推進部 スタートアップグループ主査 馬場大輔様に講師を務めていただき座談会を開催しました。
|
講演会後の集合写真 |
更新日:2023年4月25日
卓越大学院プログラムGD4年片桐健さん GD3年齋藤祐功さん GD2年味田渉さん(中山研)がThe American Ceramic SocietyのICACC2023に参加しました
卓越大学院プログラム 中山研 GD4年片桐健さん(長岡高専出身)、GD3年齋藤祐功さん(長岡高専出身)、GD2年味田渉さん(室蘭工業大学出身)(※いずれも参加時学年)が1月22日~27日にアメリカ合衆国フロリダ州にて開催されましたThe American Ceramic Societyの47th International Conference and Expo on Advanced Ceramics and Composites(ICACC2023)に参加し、口頭発表を行いました。
セクションはS11: Advanced Materials and Innovative Processing Ideas for Production Root Technologiesにて実施いたしました。
https://ceramics.org/event/47th-international-conference-and-expo-on-advanced-ceramics-and-composites-icacc2023-archive
![]() 口頭発表会場の集合写真 |
![]() ポスター会場の集合写真 |
更新日:2023年4月25日
卓越大学院プログラムGD2年 穂積将輝さん(中山研)が「熱応答性自己折り畳みプロセスを有するロボットの制御手法の確立」というテーマで海外リサーチインターンシップを行いました
卓越大学院プログラムGD2年(実習時学年)穂積 将輝さん(中山研、宇部高専出身)がイギリスのシェフィールド大学において2月下旬から約1ヶ月間「熱応答性自己折り畳みプロセスを有するロボットの制御手法の確立」というテーマで海外リサーチインターンシップを行いました。
熱応答性のあるスマートマテリアルを用いたストリング状の自己折り畳みプロセスを有する樹脂複合体ロボットの開発を行いました。
現地でチューターをしてくれた学生と共に論文を作成することを目標に研究活動を行いました。すべての活動を英語で行う経験は日本ではなかなかすることができず、貴重な経験となりました。 過去の留学経験から想像できるような内容ではなく、レベルの高い研究活動を行う必要があり、自分の力不足を実感するとともに、海外発展リサーチインターンシップの実施に向けて、日本国内で様々な勉強や対策を行うモチベーションを得ることができました。
同大学で、全力で研究に取り組む姿を見て、自分自身の今後の研究活動の刺激になりました。
|
配属先研究室の宮下先生と |
更新日:2023年4月25日
卓越大学院プログラムGD3年 沈志明さん(中山研)が「走査型電子顕微鏡を用いて非破壊で材料接合面の評価」というテーマで海外リサーチインターンシップを行いました
卓越大学院プログラムGD3年(実習時学年)沈志明さん(中山研、上海大学出身)がイギリスのヨーク大学において2月下旬から約1ヶ月間「走査型電子顕微鏡を用いて非破壊で材料接合面の評価」というテーマで海外リサーチインターンシップを行いました。
材料接合面の評価は従来、試料の断面を作製した上で、TEMで観察するのが一般的でした。 今回の研究では、SEMの加速電圧を制御し、TEMに近い分解能を維持しながら、非破壊で材料接合面の内部構造を観察ができるようになりました。
![]() Prof.Atsufumiとの写真 |
![]() Prof.Li,Dr.David, Prof.Atsufumiとの写真 |
![]() 実験室の風景 |
![]() 研究室メンバーと食事 |
更新日:2023年3月16日
卓越大学院プログラムGD4年畠山幸太さん(高橋研)が「グローブ浸漬工程のカルシウム凝固に関する研究」というテーマで海外リサーチインターンシップを実施しました
卓越大学院プログラムGD4年畠山幸太さん(高橋研、長野高専出身)が英国のUniversity of Cambridge にて2022年10月31日から約4か月半、「グローブ浸漬工程のカルシウム凝固に関する研究」というテーマで海外リサーチインターンシップを行いました。
近年ゴム手袋の需要はCovid-19の影響などもあり増え続けています。本研究では、材料の水分含有量を減らすことで蒸発工程のエネルギーコスト減少に向けて、より優れた強度を持つ手袋を作成するための条件解明などに向けて取り組みました。
世界最高峰の教育研究機関での活動は非常に貴重な経験となりました。
![]() Prof.Alex Routhとの写真 |
![]() Dr.Bob Grovesとの写真 |
更新日:2023年3月7日
卓越大学院プログラムGD4年 片桐健さん(中山研)が「ストリング状の自己折り畳みロボットの開発」というテーマで海外リサーチインターンシップを行いました
卓越大学院プログラムGD4年 片桐健さん(中山研、長岡高専出身)がイギリスのSheffiled大学において2ヶ月間「ストリング状の自己折り畳みロボットの開発」というテーマで海外リサーチインターンシップを行いました。
温度変化を変形のトリガーとするスマートマテリアルを用いたストリング状の樹脂複合体ロボットの開発を行いました。日本国内と海外で研究への向き合い方の違いを実感するとともに、現地の学生と論文作成を目指して一緒に研究を進めていく経験を得ることができました。
専門用語が飛び交う内容をネイティブスピーカーと綿密に行う必要があり、これは自分の想像を遥かに超えるほど難しく、新たな自分の課題を見つけることができました。また、同大学には世界中から同年代の学生が留学し、博士号取得のために異国の地で日々努力している姿に触れることができ、そのモチベーションの高さに刺激を受けました。
|
マイクロロボット研究室の学生たちとの集合写真 |
更新日:2023年3月7日
卓越大学院プログラムGD4年 安田匠さん(伊東研)が「Development of Large-Scale Rapid EV charging system」というテーマでプロジェクトリーダ実習を実施しました
卓越大学院プログラムGD4年 安田匠さん(伊東研、神戸高専出身)が2022年12月3日~2023年2月26日まで、ノルウェーのSINTEF Energy Researchにおいてプロジェクトリーダ実習を行いました。
大都市では、多数のEVを充電するためのEV充電器の体積とコストが問題となっています。本プロジェクトでは、数百台のEVを同時に充電可能な小型高速マルチポートEV充電システムの制御システムの実験的検証を行いました。
提案した制御を用いることによって、従来に比較してEVの充電速度を2倍以上高速化することができます。また、高効率制御を提案することによって、EV充電システムに発生する電力損失を低減しました。
![]() 作業の様子 |
![]() 実機試験回路 |
更新日:2023年2月9日
技術科学イノベーション系 中山教授、山口教授、環境社会基盤系 渡利助教、卓越大学院プログラム 山口研 GD3年蔵下はづきさん、GD2年永井孔明さん、永井麻実さんが新潟県佐渡市で開催された「佐渡島 天地人サイエンスプロジェクト2022」に出展しました
2022年7月30日、31日に技術科学イノベーション系 中山教授、山口教授、環境社会基盤系 渡利助教、卓越大学院プログラム 山口研 GD3年蔵下はづきさん(都城高専出身)、GD2年永井孔明さん(長岡高専出身)、永井麻実さん(京都府立大学出身)が新潟県佐渡市で開催された「佐渡島 天地人サイエンスプロジェクト2022」にブースを出展しました。
当日は小・中・高生75名の参加があり、SDGsや水害と電気に関する知識や行動への理解を深めてもらうことができました。また、出展の内容は2022年8月2日発刊の新潟日報にも掲載されました。
![]() SDGsに関するレクチャー |
![]() ブレーカ水没・復旧実験 |
更新日:2023年1月11日
卓越大学院プログラムGD4年大畠慶太さん(伊東研)が、「パワーエレクトロニクス向け高速コントローラの開発」というテーマでプロジェクトリーダー実習を実施しました。
卓越大学院プログラムGD4年大畠慶太さん(伊東研、茨城高専出身)がヘッドスプリング株式会社(東京都品川区)にて10月3日から12月28日までの約3ヶ月間、プロジェクトリーダー実習を行いました。ヘッドスプリング株式会社は、EV充電器や直流回生電源をはじめとしたパワーエレクトロニクス(パワエレ)製品を手掛ける新興メーカーです。
今回のインターンシップでは、高速リアルタイム演算が可能なパワエレ製品向けコントローラの設計開発を行いました。一連の業務体験を通じて製品開発の難しさに触れ、実用的な学びを得ました。
![]() |
![]() |
![]() |
USPM用コントローラ→内閣府の戦略的イノベーション創造プログラム(SIP)の中で開発された汎用的な超高速コントローラ。最大50MHzの高速サンプリングを生かした精密な制御が可能で、幅広いパワエレ機器に応用できます。
※ USPM: Universal Smart Power Module は主回路、制御回路、ゲートドライバ、ノイズフィルタなどパワエレに必要な部品を1パッケージに統合した電力変換モジュール。USPMを複数台組み合わせることで容易に様々なパワエレ製品を開発することができます。
更新日:2022年12月28日
卓越大学院プログラムGD4年AMALINA AINA BINTI KAHARUDINさん(本間研)が、「6082アルミニウム合金のVDA曲げ性および粒界腐食感受性に及ぼすCuおよびSiの影響」というテーマで海外発展リサーチインターンシップを実施しました
卓越大学院プログラムGD4年AMALINA AINA BINTI KAHARUDINさん(本間智之研、クアラルンプール大学出身)が、名古屋市にある株式会社UACJ R&Dセンターにおいて、2022年12月5日から12月23日まで海外発展リサーチインターンシップをオンラインと対面で実施しました。
インターンシップの研究テーマは「6082アルミニウム合金のVDA曲げ性および粒界腐食感受性に及ぼすCuおよびSiの影響」であり、自動車のバンパー用形材への応用に着目しました。
12月22日から12月23日まで株式会社UACJを訪問しました。22日に実験結果についてディスカッションを行い、23日に最終発表会で成果発表を行いました。
|
訪問時の写真 |
更新日:2022年11月7日
卓越大学院プログラムM2年坂口穂貴さん(石橋研)が「磁性薄膜の全光学磁化反転に関する研究」というテーマで海外リサーチインターンシップを実施しました
卓越大学院プログラムM2年坂口穂貴さん(石橋研、奈良高専出身)が茨城県つくば市にある物質・材料研究機構において2022年8月23日から約2カ月間、「磁性薄膜の全光学磁化反転に関する研究」というテーマで海外リサーチインターンシップを行いました。
光を照射するだけで磁性体の磁化を操作する全光学磁化反転現象は、限られた磁性体でのみ実証されています。今回は、実証例の無いFePt薄膜に微細加工等の材料設計の観点から全光学磁化反転を検証しました。
![]() 磁性薄膜の作製に使用したスパッタリング装置 |
![]() 全光学磁化反転の実験光学系 |
更新日:2022年11月7日
卓越大学院プログラムGD5年山口直也さん(南口研)がMatching HUB Nagaoka 2022にブースを出展しました
卓越大学院プログラムGD5年山口直也さん(南口研、長野高専出身)が、新潟県長岡市にあるアオーレ長岡で10/23(日)-24(月)に行われたMatching HUB Nagaoka 2022に、長岡工業高等専門学校 精密加工研究室/長岡技術科学大学 高温材料研究室共同でブースを出展しました。
出展題目は「新しい耐熱材料: MAX相セラミックス」であり、高い耐酸化性や一般的なセラミックスであるアルミナと同等以上の機械的特性を持つ上、超硬合金製工具での切削加工も可能な最先端材料であるTi2AlC MAX相セラミックスについて紹介しました。
|
ブースでの写真 |
更新日:2022年10月4日
卓越大学院プログラムGD5年山口直也さん(南口研)がTi2AlC MAX相セラミックスの自己治癒能力測定のためのき裂導入法の確立というテーマでプロジェクトリーダー実習を実施しました
卓越大学院プログラムGD5年山口直也さん(南口研、長野高専出身)が、茨城県つくば市にある物質・材料研究機構において、2022年7月26日から約2か月、プロジェクトリーダー実習を行いました。
実習テーマは「Ti2AlC MAX相セラミックスの自己治癒能力測定のためのき裂導入法の確立」というもので、長田俊郎博士らの研究グループと共にTi2AlCの破壊挙動を観察するための装置や手法の開発に関するプロジェクトを実施しました。
これは、最先端材料であるTi2AlC MAX相セラミックスの社会実装を目的としたプロジェクトであり、ルートテクノロジーを体現したものとなりました。
|
走査電子顕微鏡で導入したき裂を観察している様子 |
更新日:2022年10月3日
卓越大学院プログラムGD4年安田匠さん(伊東研)が「モジュラーマルチレベル変換器のオンライン劣化診断と信頼性向上」というテーマで海外発展リサーチインターンシップを実施しました
卓越大学院プログラムGD4年安田匠さん(伊東研、神戸高専出身)が2022年7月1日~9月30日までの3か月、九州工業大学で海外発展リサーチインターンシップを行いました。
モジュラーマルチレベル変換器は、これまでの電力変換器よりも高電圧かつ大容量領域での電力変換動作を可能とし、インフラ等の基幹インフラに適用が期待されます。一方で、モジュラーマルチレベル変換器の実用化には信頼性の向上が課題の1つです。
本研究では、オンラインでモジュラーマルチレベル変換器の劣化診断を行う技術の開発に取り組みました。
本技術によって、モジュラーマルチレベルコンバータの信頼性設計方針を明らかにします。
|
|
![]()
|
更新日:2022年9月21日
技術科学イノベーション系兼環境社会基盤系 山口教授、環境社会基盤系 渡利助教、GD4三輪徹さん(山口研)、GD1原田隆大さん(山口研)、GD1吉村凌弥さん(山口研)が国際会議「第2回国際水環境シンポジウム The 2nd international symposium on Water Environment for Young researchers’ Network (WEYN)」の企画及び運営を行いました
技術科学イノベーション系兼環境社会基盤系 山口教授、環境社会基盤系 渡利助教、GD4三輪徹さん(山口研、豊田高専出身)、GD1原田隆大さん(山口研、鹿児島高専出身)、GD1吉村凌弥さん(山口研、鹿児島高専出身)が国際会議「第2回国際水環境シンポジウム The 2nd international symposium on Water Environment for Young researchers’ Network (WEYN)」の企画及び運営を行い、2022年9月2日に山梨大学甲府キャンパスで開催しました。
当日は50名を超える学生及び教員が参加し、ポスター発表をとおしてお互いの研究についてディスカッションを行いました。
![]() 発表の様子① |
![]() 発表の様子② |
更新日:2022年8月31日
卓越大学院プログラムM2年岡田瞬さん(庄司研)が、「生体内発電可能なリポソーム型バイオ燃料電池の開発」というテーマで海外リサーチインターンシップを実施しました
卓越大学院プログラムM2年岡田 瞬さん(庄司研、米子高専出身)が2022年5月23日~8月10日までの2か月半、東京農工大学 川野研究室で海外リサーチインターンシップを行いました。
派遣先では、キャピラリマイクロ流体デバイスを用いて、細胞膜の主成分である脂質二分子膜で構築されたリポソームを調製する手法の検討を行いました。本手法を用いることで、ハイスループットに単分散なリポソームを調製することが可能です。
![]() 実習期間中に農工大で行われた学会に参加した様子 |
![]() 作成したリポソーム |
更新日:2022年8月31日
卓越大学院プログラムM2年小岩滉宜さん(庄司研)が、「リポソームへのDNA構造体挿入に関する研究」というテーマで海外リサーチインターンシップを実施しました
卓越大学院プログラムM2年小岩滉宜さん(庄司研、一関高専出身)が、東北大学大学院工学研究科(宮城県仙台市)において、海外リサーチインターンシップ(国内)の一環として、2022年6月20日から8月26日まで研究活動を行いました。
インターンシップの研究テーマは「リポソームへのDNA構造体挿入に関する研究」であり、派遣先では、DNAによって作製されたナノオーダーの構造体を細胞様小胞(リポソーム)へ挿入するための実験環境の構築および、DNA構造体の挿入性評価をするため蛍光顕微鏡を用いたリポソームの蛍光測定を実施しました。
![]() 蛍光計測のための実験環境 |
![]() 蛍光測定の様子 |
更新日:2022年8月25日
卓越大学院プログラムGD2年土田脩斗さん(山田研)が、「両面受光型太陽光発電の光学的解析に関する研究」というテーマで海外リサーチインターンシップを実施しました
卓越大学院プログラムGD2年土田脩斗さん(山田研、長岡高専出身)が、産業技術総合研究所 福島再生可能エネルギー研究所(福島県郡山市)において、海外リサーチインターンシップ(国内)の一環として、2022年6月~7月のうち2週間、「両面受光型太陽光発電の光学的解析に関する研究」というテーマで研究を行いました。
派遣先では、両面受光太陽電池アレイのフレームや梁などによる部分影が発電特性に及ぼす影響を実験とシミュレーションにより評価を行いました。
![]() 両面受光太陽電池アレイ |
![]() 共同企業とのディスカッションの様子 |
更新日:2022年8月8日
卓越大学院プログラムGD4年AMALINA AINA BINTI KAHARUDINさん(本間研、クアラルンプール大学出身)が、「6082アルミニウム合金のVDA曲げ性および粒界腐食感受性に及ぼすCuおよびSiの影響」というテーマで海外リサーチインターンシップを実施しました。
卓越大学院プログラムGD4年AMALINA AINA BINTI KAHARUDINさん(本間智之研、クアラルンプール大学出身)が、名古屋市にある株式会社UACJ R&Dセンターにおいて、2022年6月13日から8月5日まで海外リサーチインターンシップをオンラインと対面で実施しました。
インターンシップの研究テーマは「6082アルミニウム合金のVDA曲げ性および粒界腐食感受性に及ぼすCuおよびSiの影響」であり、自動車のバンパー用形材への応用に着目しました。
2022年6月29日から7月1日まで株式会社UACJで工場見学をして、サンプルの作製も行いました。サンプルの観察および解析は長岡技術科学大学で行いました。
最終発表会は、株式会社UACJで行う予定でしたが、コロナウィルスの感染者数が増加していたため、オンラインに変更し実施しました。
更新日:2022年7月28日
技術科学イノベーション系兼環境社会基盤系 山口教授、環境社会基盤系 渡利助教、卓越大学院プログラムGD4三輪徹さん、GD2永井漸さんが鹿児島県長島町で開催された「わくわく科学教室in長島」に出展しました
2022年7月23日、24日、技術科学イノベーション系兼環境社会基盤系 山口教授、環境社会基盤系 渡利助教、卓越大学院プログラムGD4三輪徹さん(山口研、豊田高専出身)、GD2永井漸さん(山口研、グリニッジ大学)が鹿児島県長島町で開催された「わくわく科学教室in長島」に出展しました。
3年ぶりの開催となった科学教室には二日間で合計180名が参加し、子どもたちと科学の楽しさを共有しました。
![]() 科学教室の様子① |
![]() 科学教室の様子② |
更新日:2022年7月6日
特別ゲストを招待して座談会並びにビジネスプラン発表会を開催しました。
6月2日に座談会、6月3日にビジネスプラン発表会を開催しました。
座談会では、Gavi, the Vaccine Alliance 高橋特任教授、株式会社日立製作所 加藤様、スプライン株式会社 次重 特任准教授をお招きし、本学の卓越大学院生とキャリアパスなどについてディスカッションを行いました。ビジネスプラン発表会においては、office 天羽 代表 天羽氏(元デュポン株式会社 名誉会長)を始め10名の方にコメンテーターを務めていただきました。
発表者は、佐藤特任助教、GD3齋藤祐功さん(中山研、長岡高専出身)、GD2穂積将輝さん(中山研、宇部高専出身)、GD2味田渉さん(中山研、室蘭工業大学出身)、GD2豊場亮太さん(大塚研、豊田高専出身)、M1吉田健太郎さん(鈴木研、日本大学出身)が務めました。
|
ビジネスプラン発表会後の集合写真 |
更新日:2022年5月2日
卓越大学院プログラムGD4年三輪徹さん、GD3年蔵下はづきさん、GD2年永井麻実さん、GD2年永井孔明さん、M2年根津拓福さん、M2年山田光陽さん、GD1年原田隆大さん、M1年中久保敬悟さん、M1年吉村凌弥さん(以上山口研)、GD2年味田渉さん(中山研)が国際会議「The 1st international symposium on Water Environment in Yamanashi University and Nagaoka University of Technology」の企画・運営を行いました。
卓越大学院プログラムGD4年三輪徹さん、GD3年蔵下はづきさん、GD2年永井麻実さん、GD2年永井孔明さん、M2年根津拓福さん、M2年山田光陽さん、GD1年原田隆大さん、M1年中久保敬悟さん、M1年吉村凌弥さん(以上山口研)、GD2年味田渉さん(中山研)が国際会議「The 1st international symposium on Water Environment in Yamanashi University and Nagaoka University of Technology」の企画及び運営を行い4月8日にNaDeCBaseで開催しました。
総勢30名を超える学生及び先生が参加し、ポスター発表を通じてお互いの研究のディスカッションを行いました。
※コロナ対策は施設のルールに準拠し実施しました。
![]() |
![]() |
![]() |
更新日:2022年4月26日
卓越大学院プログラムGD2年沈志明さん(中山研、上海大学出身)が産総研において、令和3年度産総研イノベーションスクールを修了しました。
卓越大学院プログラムGD2年(修了時学年)沈志明さん(中山研、上海大学出身)が、2021年10月~2022年3月の6ヶ月間に令和3年度産総研イノベーションスクールの研究基礎力育成コースに参加しました。
産総研中部センター(名古屋市)のマルチマテリアル研究部門でポリマー複合材料の研究開発に関する技術研修をしました。将来、研究者として自立するための研究スキルを磨くことを目的として、各大学からの異分野の研究者と共に、オンラインの講義・演習を受けました。
![]()
|
![]()
|
更新日:2022年4月4日
卓越大学院プログラムGD3年齋藤祐功さん、GD2年味田渉さんが、「スマートファクトリーコーディネーター」というテーマでプロジェクトリーダー実習を実施いたしました。
環境・プロセスデザイン研究室の卓越大学院プログラムGD2年(実習時学年)齋藤祐功さん、GD1年(実習時学年)味田渉さんが、2021年8月~11月の間、新潟エアロスペース株式会社、株式会社メビウス、新潟市役所成長産業支援課でプロジェクトリーダー実習を行いました。実習テーマは「スマートファクトリーコーディネーター」で、新潟市が実施してる製造業DXプロジェクトに参加し、知見を活かしプレイングマネジメントとして業務を行いました。加えて、プロジェクトの提案企業、参加企業でも業務を行い、例えば航空宇宙分野の国際展示商談会のAeromart NAGOYAに出展や新潟県内の企業分布調査などを行いました。DXを理解すると共に、新潟に適したDXを考えながら、プロジェクトの推進の難しさを学び、3つの産官で実習が出来たことが知見を広め大変貴重な経験が出来ました。
◎参加製造業DXプロジェクトHP- https://intro.produconnect.jp/
![]() 製造業DXプロジェクトメンバー並びに株式会社メビウス |
![]() 新潟エアロスペース株式会社 |
![]() 新潟市役所成長産業支援課 |
![]() Aeromart NAGOYAでの新潟エアロスペース株式会社の出展ブース |
更新日:2022年3月29日
卓越大学院プログラムGD4年大川采久さん(環境・プロセスデザイン研究室)が、「製造業における、これからの時代に求められる企業の在り方の模索、及び企業変革の推進方法」のテーマでプロジェクトリーダー実習を実施しました
卓越大学院プログラムGD4年大川采久さん(環境・プロセスデザイン研究室、苫小牧高専出身)がSpline株式会社(東京都)において、プロジェクトリーダー実習を実施しました。主に、DX推進やAIに関する研究開発型新事業創造に携わりました。
ビジネスに基づいた研究に対する考え方を学び、新たな角度から研究開発を俯瞰することで、社会実装実践力を培いました。
更新日:2022年3月29日
卓越大学院プログラムGD2年安原雅貴さんが、「音楽家の調子をコンディショニングするBCI (Brain computer interface)の開発」というテーマでプロジェクトリーダー実習を実施しました
卓越大学院プログラムGD2年安原雅貴さんが、2021年12月〜2022年3月の間、Sony Computer Science Laboratories, Inc. 古屋晋一先生の研究グループでプロジェクトリーダ実習を行いました。実習テーマは「音楽家の調子をコンディショニングするBCI (Brain computer interface)の開発」で、調子が良い時と悪い時の脳波を計測し、演奏会の前などに調子がいい脳波となるようにフィードバックをかけることで、不調に悩まされることがなく常に最高のパフォーマンスを発揮できるようにする研究です。
この実習を通じて、何人ものプロの演奏家の脳波を計測・解析することができて大変貴重な経験となったそうです。
|
更新日:2022年3月29日
まちなかキャンパス長岡にて電光掲示板を製作する電子工作講座を行いました
2022年1月15、22、29日の3日間にわたって、電光掲示板を製作する電子工作講座をまちなかキャンパス長岡にて行いました。中学生~70代の幅広い年代の受講者さん6名にご参加いただきました。
実際に使われていた電車の電光掲示板を使った原理の説明、マイコンボードArduinoを使用したC言語のプログラミング、ブレッドボードでの回路の組み立てを通して、電子工作を楽しんでいただきました。
◎本講座の企画学生
卓越大学院プログラム 技術科学イノベーション専攻
3年:大畠慶太(伊東研),安田匠(伊東研),山口正通(伊東研),片桐健(中山研)
2年:楠居 琳太郎(伊東研),西川滉大(伊東研)
1年:大倉惇稔(伊東研)
◎講座の詳細 Go to 電子工作 -バスや電車の行先を示す 電光掲示板をつくろう!- https://www.machicam.jp/course/2021/shimin-05.html
![]() 講座の様子 |
![]() 電車の電光掲示板を使った説明 |
![]() 完成した回路 |
![]() 受講生との集合写真 |
更新日:2022年2月18日
国際ジャーナル Analytical Chemistry (ACS Publications)にて、卓越大学院プログラムGD5年中村彰宏さん(発酵科学研究室、新発田南高校出身)らの論文がサポーティングジャーナルカバーに選出されました
2022年2月8日、発酵科学研究室(小笠原研究室)卓越大学院プログラムGD5年中村彰宏さんらの論文「7‐Aminocoumarin-4-acetic acid as a fluorescent probe for detecting bacterial dipeptidyl peptidase activities in water-in-oil droplets and in bulk」が国際ジャーナルAnalytical Chemistry (IF 6.986) に掲載され、同誌のサポーティングジャーナルカバーに選出されました。
掲載されたカバーアート |
更新日:2022年1月26日
卓越大学院プログラムGD4年大川采久さん(中山研)が大学院教育改革フォーラム2021にて優秀賞を受賞しました
2022年1月8日、卓越大学院プログラムGD4年大川采久さん(中山研)が、大学院教育改革フォーラム2021におけるポスターセッションにて、「Development of Environmental Barrier Coatings with Repeated Self-healing」と題した発表が優秀賞を受賞しました。
また、京都大学・名古屋大学の学生らと共同で取り組んだワークショップでは、異分野融合部門にて、「過酷環境・極端現象から生存するための素材・システムが駆動するデジタル防災社会の構想」と題した提案が優秀賞を受賞しました。
参考
https://itgp.osaka-u.ac.jp/forum2021/news/2022/0124175633635/
更新日:2022年1月26日
卓越大学院プログラムGD4年山口直也さん(南口研)が、Ti2AlCセラミックスの表面処理と有機物との高温密着性というテーマで海外反復リサーチインターンシップを行ってきました
卓越大学院プログラムGD4年山口直也さん(南口研)が、長野県長野市にある長野工業高等専門学校において、2021年12月1日から約1か月半のリサーチインターンシップを行ってきました。実習テーマは「Ti2AlCセラミックスの表面処理と有機物との高温密着性」というもので、柳澤憲史准教授らの研究グループと共にTi2AlCの表面テクスチャを変化させるための表面処理や加工、Ti2AlCの濡れ性や高温密着性を測定する試験を実施しました。
また、インターン中に研究機器相互利用ネットワーク導入実証プログラム(SHARE)にて構築した「技学イノベーション機器共用ネットワーク」を利用して、遠隔で長岡技大の観察機器を操作してTi2AlCの表面観察を行いました。これは、最先端材料であるTi2AlC MAX相セラミックスの社会実装を目的としたプロジェクトであり、ルートテクノロジーを体現したものとなりました。
![]() 山口さんと担当教員 |
![]() 遠隔操作で長岡技大の観察機器を操作している様子 |
更新日:2022年1月26日
卓越大学院プログラムGD4年山口直也さん(南口研)、渡利友紀さん(佐野研)、GD3年三輪徹さん(山口研)、GD1年豊場亮太さん(大塚研)、永井麻実さん(山口研)が 東北大学×長岡技術科学大学×名古屋大学 卓越大学院プログラム共同workshop「共創奇人〜バックグラウンドの違う人が集まったら何が生まれるか〜」に参加しました
令和3年12月27日(月)に名古屋大学で行われた、東北大学×長岡技術科学大学×名古屋大学 卓越大学院プログラム共同workshop「共創奇人〜バックグラウンドの違う人が集まったら何が生まれるか〜」に卓越大学院プログラムGD4年山口直也さん(南口研)、渡利友紀さん(佐野研)、GD3年三輪徹さん(山口研)、GD1年豊場亮太さん(大塚研)、永井麻実さん(山口研)が参加しました。このワークショップには名古屋大学「未来エレクトロニクス創成加速DII協働大学院プログラム」の学生と、長岡技大「グローバル超実践ルートテクノロジープログラム」の学生と、東北大学「変動地球共生学卓越大学院プログラム」の学生と、金城学院大学大学院の学生が参加しました。
このイベントは研究発表とワークショップを併催するセミナーを、名古屋大学、東北大学、長岡技術科学大学に所属する学生が中心となって企画・開催することにより、参加者の学際性を向上させ、異分野理解および協働能力を習得することを目的として開催されました。さらにそのセミナーをより良いものにするために、金城学院大学大学院で心理学を専門にしている博士学生にワークショップの監修をお願いしました。
長岡技大5名、東北大学1名、名古屋大学2名、金城学院大1名の計9名がイベントに参加し、研究交流、レゴを用いたアイデア出しを行いました。様々なバックグラウンドの参加者がいたため、多様な分野の研究情報や各大学の状況等の共有、各自の専門性に基づいたアイデア出しや意見交換を行うことができました。
参加者から「非常に有意義なワークショップだった。」「他の卓越大学院の学生とも交流したい。」などの意見をいただくことができました。 今後も卓越大学院間の学生と交流するイベントを企画していきたいと思います。
![]() レゴを用いたアイデア出しの様子 |
![]() ワークショップについての説明をしている様子 |
![]() 集合写真 |
|
更新日:2022年1月12日
卓越大学院プログラム GD2年田中太一さんが、ピアニストを限界突破させるための「筋電を用いたバイオフィードバックトレーニング」というテーマでプロジェクトリーダー実習を実施しました
卓越大学院プログラムGD2年田中太一さんが、2021年10~12月の間、Sony Computer Science Laboratories 古屋晋一さんの研究グループでプロジェクトリーダ実習を行いました。実習テーマは「筋電を用いたバイオフィードバックトレーニング」で、ピアニストに生体信号の一種である筋電から得た演奏特徴を提示することで自分一人の力だけでは到達不可能な領域へ能力を高めることを可能にする研究です。この実習を通して、新しい筋電解析法や独自の実験システムを知ることができて大変貴重な経験になりました。
|
更新日:2022年1月6日
卓越大学院プログラム 環境・プロセスデザイン研究室のGD4年大川采久さん、GD3年齋藤祐功さん、GD1年味田渉さん、GD1年穂積将輝さんらが、佐渡空港において電動航空機(無人電気飛行機)の実証実験を行いました
卓越大学院プログラムGD4年大川采久さん、GD3年齋藤祐功さん、GD1年味田渉さん、GD1年穂積将輝さんらが電動航空機を用いて、2016年8月からドローンやロボットの遠隔操縦に利用できるようになった周波数帯を利用してハンドオーバー試験を佐渡空港(2021年10月4日~6日)において実施しました。昨年度も佐渡空港を用いて実験を行い、ルートを昨年と変更して実施しました。
本実験は東京農工大学、新明和工業(株)、NICT(情報通信研究機構)、一般財団法人 総合研究奨励会との共同事業となります。
このように卓越大学院プログラムにおいては、材料科学と電気工学と情報科学の融合したルートテクノロジーに関する実践的な取り組みに挑んでいます。
|
—-昨年の記事—-
卓越大学院プログラムGD3年大川 采久君(中山研、苫小牧高専出身)が佐渡空港において電動航空機(無人電気飛行機)の実証試験を行いました
更新日:2021年12月24日
卓越大学院プログラム GD2年齋藤祐功さん、GD2年沈志明さん、GD2年小林勇斗さんがメンバーである Phoenix Robots がロボットコンテストの国際大会で 1st Prize を受賞しました
卓越大学院プログラムGD2年齋藤祐功さん、GD2年沈志明さん、GD2年小林勇斗さんがメンバーである Phoenix Robots が2021年の夏に開催された国際大会 RoboMaster2021 Online Assessment 部門に出場し、1st Prizeを受賞しました。昨年に続き、感染症流行により渡航できずにオンラインで大会が実施されました。これも、本学並びに約40の企業・団体等のご支援・ご協力の賜物であります。
![]() 受賞メンバー |
賞状 |
大会結果
https://www.robomaster.com/en-US/resource/pages/announcement/1350
Phoenix Robots HP
https://phoenix-robots.com/
更新日:2021年12月03日
卓越大学院プログラム環境・プロセスデザイン研究室のGD1年 穂積将輝さんがMatching HUB Hokuriku 2021 Matching HUB Business Idea & Plan competition(M-BIP)に参加し、オーディエンス賞を受賞しました
卓越大学院プログラムの環境・プロセスデザイン研究室GD1年 穂積将輝さん(宇部高専出身)が、2021年11月に開催された、「地域の若い力をイノベーションにつなげることを目的とした、学生のビジネスアイデアコンテストM-BIP」に参加しました。Matching HUB Hokuriku 2021展示会場内で行われたポスターセッションにおいて、来場者の投票によりオーディエンス賞が決まり、穂積将輝さんが代表のチーム「GIFTALK」が受賞いたしました。
<穂積さんからのコメント>
前期に行われたリーンローンチパッドプログラムに続き、M-BIPでのオーディエンス賞を受賞でき大変光栄に思います。これからもこのアイデアをより良いものにし、事業化までできたらよいと考えております。
ビデオ通話×オンラインショッピングサービス「GIFTALK」 代表:穂積将輝
![]() オーディエンス賞を受賞した穂積さん |
|
更新日:2021年11月30日
卓越大学院プログラムGD4年 大川采久さん(中山研)がNaDeC BASEポスターデザインコンテストにて優秀賞を受賞しました
2021年10月25日、卓越大学院プログラムGD4年大川采久さん(中山研究室)がNaDeC BASEポスターデザインコンテストにて優秀賞を受賞しました。
![]() 表彰式の様子 |
|
NaDeC BASEポスターデザインコンテスト 結果発表&表彰式の様子
https://www.nadec-base.jp/2021/10/27/nadec-base-posterceremony/
更新日:2021年11月25日
卓越大学院プログラムGD4年山口直也さん(南口研、長野高専出身)、GD3年 三輪徹さん(山口研、豊田高専出身)、GD1年永井麻実さん(山口研、京都府立大学出身)が第2回佐渡未来講座「ローカルSDGsシンポジウム」、第1回さど未来創造・戦略推進会議に参加しました
2021年11月21日、卓越大学院プログラムGD4年山口直也さん(南口研、長野高専出身)、GD3年 三輪徹さん(山口研、豊田高専出身)、GD1年永井麻実さん(山口研、京都府立大学出身)が、佐渡市にて行われた第2回佐渡未来講座「ローカルSDGsシンポジウム」、および第1回さど未来創造・戦略推進会議に参加しました。また卓越大学院プログラムに係る佐渡キャンパスの視察もおこないました。世界の最新の動向を踏まえながら、佐渡市総合戦略アドバイザーや学識者・専門家のご講演を拝聴し、佐渡島SDGs・地域循環共生圏づくりの理解や実践について考えを深めることができました。
![]() |
更新日:2021年11月25日
卓越大学院プログラムGD4年 大川 采久さん(中山研)らの論文がAdvanced Materials Interfaces誌のInside Front Coverに採択されました
2021年11月23日、卓越大学院プログラムGD4年大川采久さん(中山研究室)らが執筆した、研究論文「Titanium Nitride and Yttrium Titanate Nanocomposites, Endowed with Renewable Self-Healing Ability」が国際学術雑誌 Advanced Materials Interfacesに掲載され、Inside Front Coverとして採択されました。 雰囲気制御による相転移に基づく、亀裂修復および修復剤の再生に成功しました。
|
|
Advanced Materials Interfaces掲載
https://onlinelibrary.wiley.com/doi/10.1002/admi.202170126
更新日:2021年11月22日
日本セラミックス協会 第34回秋季シンポジウムにて卓越大学院プログラム GD2年齋藤祐功さん(中山研、長岡高専出身)(主著)らの研究発表がFighting-spirit awardを受賞しました
卓越大学院プログラムGD2年齋藤 祐功さん(中山研、長岡高専出身)(主著)、(共同研究者 吉田 寛さん、GD5年杉山 大晴さん(中山研、鹿児島高専出身)、GD5年 長尾 和樹さん(江研、香川高専出身)ら)の発表「Effect of Applied Electric Field on Low Temperature Bonding Method by Applying Nanosecond Pulsed Electric Field to Silver Nanoparticles」が公益社団法人日本セラミックス協会 第34回秋季シンポジウムでMaterial Design and Processing Design SessionのFighting-spirit awardを受賞しました。
![]() |
公益社団法人日本セラミックス協会 第34回秋季シンポジウムHP
https://fall34.ceramic.or.jp/
更新日:2021年11月17日
卓越大学院プログラム GD2年齋藤祐功さん(中山研、長岡高専出身)(主著)、GD4年山口直也さん(南口研、長野高専出身)らが、公益財団法人マザック財団の優秀論文賞を受賞しました
卓越大学院プログラムGD2年齋藤祐功さん(中山研、長岡高専出身)(主著)、GD4年山口直也さん(南口研、長野高専出身)らが執筆した、研究論文「Electrical Discharge Machining by Using MAX Phase Ceramic Tool Electrodes」が高度生産システム技術の進歩に寄与することが認められ、公益財団法人マザック財団より優秀論文賞を頂きました。
![]() |
公益財団法人マザック財団HP 受賞者リスト
http://www.mazak-f.or.jp/04b20.html
更新日:2021年11月16日
Tran Phuong Thao, GD5, had Advanced International research internship at National Institute for Environmental Studies in Tsukuba
Tran Phuong Thao, GD5 student of WISE program, has done her Advanced International research internship with Prof. Syutsubo Kazuaki in Regional Environment Conservation Division, National Institute for Environmental Studies in Tsukuba from August 1st to October 30th, 2021.The relationship between nitrogen removal and pathogen (E.coli as an indicator)removal in a laboratory-scale aerobic trickling filter (i.e., Down-flow Hanging Sponge reactor) was evaluated. This advanced internship is a valuable experience to broaden and strengthen the research network with other experts.
卓越大学院プログラムGD5年Tran Phuong Thaoさんが国立環境研究所にて海外発展リサーチインターンシップを行いました
卓越大学院プログラムGD5年Tran Phuong Thaoさんが、2021年8月1日から10月30日までの3カ月間、国立研究開発法人 国立環境研究所 地域環境保全領域の珠坪一晃先生のもとで海外発展リサーチインターンシップを実施しました。(新型コロナウイルスの影響で国内でのインターンシップになります。) 今回のインターンシップでは、実験室スケールの好気性散水ろ床リアクター(Down-flow Hanging Sponge リアクター)における衛生指標菌(大腸菌)と窒素の除去の関係性について評価しました。国立環境研究所では環境問題に関する様々な分野の研究者の話を伺うことがあり、大変貴重な経験になりました。
![]()
|
更新日:2021年11月15日
卓越大学院プログラムGD3年 三輪徹さん(山口研)が令和3年度土木学会全国大会 第76回年次学術講演会にて優秀講演賞を受賞しました
|
更新日:2021年11月12日
卓越大学院プログラムGD4年 大川采久さん(中山研)、山口直也さん(南口研)、渡利友紀さん(佐野研)、GD3年 三輪徹さん(山口研)が3大学間(長岡技術科学大学、東北大学、名古屋大学)の「卓越大学院生交流会」を企画・運営しました
2021年11月3日に、グローバル超実践ルートテクノロジープログラム(長岡技術科学大学)、変動地球共生学卓越大学院プログラム(東北大学)、未来エレクトロニクス創成加速DII協働大学院プログラム(名古屋大学)の学生が「卓越大学院学生有志委員会」を組織し、「卓越大学院学生交流会」を主催しました。長岡技大5名、東北大学5名、名古屋大学2名、金城学院大1名の計13名がイベントに参加し、活発な研究交流会、また学生自身の将来についてディスカッションを行いました。 様々なバックグラウンドの参加者がいたため、十人十色の未来像、研究、モチベーション、各大学の状況等、意見交換や交流を行えました。また自分たちの将来について本音ベースでの対話を行うことができました。参加者から「非常に有意義な時間だった。また参加したい。」「もっと多くの人と交流したい。」「他の卓越大学院の学生とも交流したい。」などとの意見をいただくことができました。 今後も卓越大学院間の学生と交流する別のイベントを企画していきたいと思います。
|
更新日:2021年11月11日
卓越大学院プログラム 環境・プロセスデザイン研究室GD2年齋藤祐功(中山研、長岡高専出身)さんらが、JST「SCORE(社会還元加速プログラム)大学推進型 東北地域大学発ベンチャー共創プラットフォーム」の「みちのくアカデミア発スタートアップ準備資金」に採択されました
卓越大学院プログラムGD2年齋藤祐功さん代表(共同申請:GD2年小柏悠太郎さん、GD1年味田渉さん、GD1年穂積将輝さん、GD1年永井漸さん、GD1年永井麻実さん)が、JST(国立研究開発法人科学技術振興機構)「SCORE(社会還元加速プログラム)大学推進型 東北地域大学発ベンチャー共創プラットフォーム」の「みちのくアカデミア発スタートアップ準備資金」に採択されました。本プログラムは研究成果の事業化支援プログラムです。
|
採択題目:サツマイモ粉を材料生産手法による高効率化・高付加価値手法の開拓と実証 |
更新日:2021年11月5日
卓越大学院プログラムGD2年齋藤祐功さんらの、次世代の働き方・サテライトオフィスに関する取材の様子が、長岡市発行の「市政だより10月号」に掲載されました
卓越大学院プログラムGD2年齋藤祐功さん(中山研、長岡高専出身)、M1外川佑樹さん(中山研)が、次世代の働き方・サテライトオフィスに関する役割などの疑問を解決する為、フラー株式会社の坂詰将也様(長岡技科大OB)に取材しました。その様子が長岡市発行の「市政だより10月号」に掲載されました。
![]() |
長岡市「市政だより2021年10月号」は下記URLより閲覧可能(掲載面はP5)
https://www.city.nagaoka.niigata.jp/shisei/cate02/tayori/file/0310/0310pdf/no805.pdf
https://www.city.nagaoka.niigata.jp/shisei/cate02/tayori/file/0310/0310pdf/no805_02-07.pdf
更新日:2021年11月1日
卓越大学院プログラムGD3年安田匠さんが、「次世代直流送電向け電力変換回路のオンラインメンテナンス手法の検討」というテーマで、海外リサーチインターンシップを行いました
卓越大学院プログラムGD3年安田匠さんが、九州工業大学 大学院工学研究院において、2021年8月から約3カ月間、「次世代直流送電向け電力変換回路のオンラインメンテナンス手法の検討」というテーマで、海外リサーチインターンシップを行いました(新型コロナウイルスの影響で国内でのインターンシップになります)。 近年、太陽光発電や風力発電といった再生可能エネルギーの発展によって、低コストかつ高効率な長距離直流送電技術が検討されつつあります。本研究では、長距離直流送電において電力の制御を担う電力変換回路のオンラインメンテナンス技術について検討しました。提案する手法では、直流送電を止めることなく、オンラインで電力変換回路の劣化診断を行うことができます。これにより、故障による停電のリスクを大幅に減らすことが可能となります。
![]() 数値解析による検証 |
![]() 実験の様⼦ |
更新日:2021年9月27日
卓越大学院プログラムGD2年齋藤祐功さん、他Phoenix Robotsメンバーが国際大会でFirst Prizeを受賞したことについて「新潟日報」と長岡市発行の「市政だより9月号」に掲載されました
卓越大学院プログラムGD2年齋藤祐功さん(中山研、長岡高専出身)ら他Phoenix Robotsメンバーが今年開催されたRobo Masterの国際大会でFirst Prizeを受賞したことについて、2021年9月18日の「新潟日報」と、長岡市発行の「市政だより9月号」に掲載されました。
![]()
|
新潟日報2021年9月18日 掲載記事は下記URLより閲覧可能
https://www.niigata-nippo.co.jp/news/local/20210919642692.html
長岡市「市政だより2021年9月号」は下記URLより閲覧可能(掲載面はP9)
https://www.city.nagaoka.niigata.jp/shisei/cate02/tayori/file/0309/0309pdf/no804.pdf
https://www.city.nagaoka.niigata.jp/shisei/cate02/tayori/file/0309/0309pdf/no804_8-9.pdf
Phoenix Robots のHP
https://phoenix-robots.com/
更新日:2021年9月09日
卓越大学院プログラムGD5年長尾和樹さん(パルスパワー研究室、香川高専出身)が「高電圧パルスパワー電源の開発」というテーマで、プロジェクトリーダー反復実習を実施しました
卓越大学院プログラムGD5年長尾和樹さん(パルスパワー研究室、香川高専出身)が株式会社パルスパワー技術研究所(滋賀県)において、プロジェクトリーダー反復実習を8月の1ヶ月間実施しました。パルス電源の開発の一環として、コンデンサ特性評価と、共振充電パルスパワー回路の評価および高繰り返し動作実験を行いました。これらの実験、評価を通して実際の製品設計、製品評価のノウハウを学ぶことができました。
![]()
|
更新日:2021年9月7日
卓越大学院プログラムGD2年沈志明さん(中山研、上海大学出身)が東北大学において、文部科学省ナノテクノロジープラットフォーム令和3年度学生研修プログラムに参加しました
2021年8月23日~27日、卓越大学院プログラムGD2年沈志明さん(中山研、上海大学出身)が、東北大学西澤潤一記念研究センターにおいて、文部科学省ナノテクノロジープラットフォーム令和3年度学生研修プログラムに参加しました。「MEMS フォースセンサと小型IoTモジュールの作製」というテーマで、微細加工プロセスを実習し、MEMSの基礎を習得しました。研修を通じてナノテクノロジーの最先端研究に対する理解を深めました。
![]() |
![]() |
更新日:2021年8月27日
卓越大学院プログラム環境・プロセスデザイン研究室のGD2年齋藤祐功さん、GD1年味田渉さん、GD1年穂積将輝さん、水圏土壌環境研究室のGD3年三輪徹さんらが長岡市摂田屋地域のリノベーション(機那サフラン酒本舗の池リノベーション)プロジェクトに参加し、長岡市役所に提案を行いました
卓越大学院プログラムの環境・プロセスデザイン研究室GD2年齋藤祐功さん(長岡高専出身)、GD1年味田渉さん(室蘭工業大学出身)、GD1年穂積将輝さん(宇部高専出身)、水圏土壌環境研究室のGD3年三輪徹さん(豊田高専出身)らが、2021年4月から水イノベーションハブ(代表 技術科学イノベーション専攻 山口隆司教授)主催の長岡市摂田屋機那サフラン酒本舗の池再生プロジェクトにリーダーとして参加しました。長岡技大、長岡高専専攻科の学生らと協同し、実地見学や動画制作を行い2021年7月20日にNaDeC BASEで歴史のデジタル保存・広報的視点からの提案、及び循環式養鯉技術を活用した観賞用鯉のディスプレイ方法の提案を長岡市役所に行いました。
![]() 池再生プロジェクトについて説明をする山口隆司教授 |
![]() 提案を行う齋藤さん |
更新日:2021年8月27日
卓越大学院プログラム環境・プロセスデザイン研究室のGD1年味田渉さん、GD1年穂積将輝さん、GD2年齋藤祐功さんらが実践的事業立ち上げ講座「リーンローンチパッドプログラム」DEMO DAYに参加しました
卓越大学院プログラムの環境・プロセスデザイン研究室GD1年味田渉さん(室蘭工業大学出身)、GD1年穂積将輝さん(宇部高専出身)が、2021年5月から長岡市主催の実践的事業立ち上げ講座「リーンローンチパッドプログラム」に参加しました。堤 孝志先生が講師を務められて、講座で4大学1高専の学生や社会人の参加者同士でチームを組み、事業立ち上げノウハウを学び、新たなビジネスアイデアを練り上げました。練り上げたビジネスをリーンローンチパッドプログラム DEMO DAY (ビジネスプラン発表会)で発表いたしました。 審査員にはKDDI株式会社の理事 松野 茂樹様や技術科学イノベーション専攻の山口隆司教授らが務められました。また、第一回目(令和元年度)の参加者として、GD2年齋藤祐功さん(長岡高専出身)も聴講いたしました。 審査の結果、穂積将輝さんが代表の「GIFTALK」がKDDI賞を受賞いたしました。
< 穂積さんからのコメント>
今回このような賞を頂けて光栄に思います。僕たちのチームは当プログラムの参加者の身の回りで起こっている悩み事を解決する方法を考え、ビジネスプランをたてました。賞をもらって終わりではなく、これからもプランの改良を重ねていきたいと考えております。
ビデオ通話×買い物サービス「GIFTALK」 代表:穂積将輝
ホテルのゲスト向け枕サブスクレンタルサービス「NEMULIER」 代表:味田渉
![]() 発表する穂積さん |
![]() 発表する味田さん |
![]() 味田さん、穂積さんと講師の堤先生 |
![]() 集合写真 |
更新日:2021年8月20日
卓越大学院プログラムGD5年杉山大晴さん(環境・プロセスデザイン研究室、鹿児島高専出身)が「低品位な変動排熱源からの高効率発電に資する材料の探索」というテーマで、海外発展リサーチインターンシップを実施しました
卓越大学院プログラムGD5年杉山大晴さん(環境・プロセスデザイン研究室、鹿児島高専出身)が、大阪大学産業科学研究所関野研究室において海外発展リサーチインターンシップを2021年7月下旬から2週間実施しました(新型コロナウイルスの影響で国内でのインターンシップになります)。「低品位な変動排熱源からの高効率発電に資する材料の探索」というテーマで、これまでに内製した材料の電気・熱特性の評価を行いました。また、これらの得られたデータを基に、時間的に温度が変動する低品位排熱源から高効率で発電できる材料の発電量と各特性の相関性を調査しました。
![]() |
![]() |
更新日:2021年6月28日
Miss Tran Phuong Thao, GD5, had Advanced Practical work for project leader education internship at National Institute for Environmental Studies in Tsukuba
As a follow-up internship of “Practical work for project leader education”, Tran Phuong Thao, GD5 student of WISE program, has done her “Advanced Practical work for project leader education” internship with Prof. Syutsubo Kazuaki in Regional Environment Conservation Division, National Institute for Environmental Studies in Tsukuba from June 1st to June 16th, 2021. Considering the performance of biological treatments for wastewater in the former internship, Down-flow hanging sponge (DHS)reactors with different material sizes were conducted to optimize the operational conditions and clarify nitrogen removal behaviors inside the DHS reactor for sewage treatment. This advanced internship is a valuable experience to broaden and strengthen the research network with other experts.
卓越大学院プログラムGD5年Tran Phuong Thaoさんが好気性ろ床法における窒素除去特性の評価というテーマで、プロジェクトリーダー反復実習を実施しました
卓越大学院プログラムGD5年Tran Phuong Thaoさんが、国立研究開発法人国立環境研究所 地域環境保全領域において2021年6月1日から2週間、珠坪一晃 先生のもとで好気性ろ床法(Down-flow Hanging Sponge、DHS)における窒素除去特性の評価というテーマで、プロジェクトリーダー反復実習を実施しました。前回のインターンシップでの経験を踏まえ、今回はDHSの担体サイズが窒素除去に及ぼす影響を評価する実験を行ったところ、担体サイズの違いで窒素の形態変化に及ぼす効果が異なることがわかりました。このような研究を通じて技術の改善や進歩に繋げていきたいと思いました。国立環境研究所では環境問題に関する様々な分野の研究者の話を伺うことがあり、大変貴重な経験になりました。
![]()
|
更新日:2021年5月7日
卓越大学院プログラムGD2年齋藤祐功さんがNHK WORLD JAPAN「NEWS ROOM TOKYO」(2021年4月22日)に出演しました
卓越大学院プログラムGD2年齋藤祐功さんがNHK WORLD JAPAN「NEWS ROOM TOKYO」(2021年4月22日)に出演しました。内容はJICAとの協働活動についてで、製作したプロトタイプが取りあげられました。協働活動は本学がハブ大学として任命されているSDGsのゴール9に関連する活動となっておりますので、ぜひご視聴ください。
オンデマンド視聴可能
https://www3.nhk.or.jp/nhkworld/en/news/videos/20210423143412158
![]() 自作した機械について説明 |
更新日:2021年4月1日
卓越大学院プログラムGD4年中村彰宏さん(発酵科学研究室、新発田南高校出身)が環境中からの産業有用微生物の探索と機能解析というテーマで、海外発展リサーチインターンシップを実施しました
卓越大学院プログラムGD4年中村彰宏さんが、山形県の鶴岡工業高等専門学校において2021年3月から1ヶ月間、斎藤菜摘准教授のもとで環境中からの産業有用微生物の探索と機能解析というテーマで、海外発展リサーチインターンシップを実施しました (新型コロナウイルスの影響で国内でのインターンシップになります)。近年、微生物を利用したものづくりの動きが国内で活発になってきています。今回は新規微生物単離の実績のある鶴岡工業高等専門学校にて、環境中からの産業有用微生物単離・機能解析を目指し、water-in-oil droplet (WODL)のという最先端の微生物培養技術を用いて、微生物の単離を試みました。
![]() |
![]() |
更新日:2021年4月1日
卓越大学院プログラムGD3年山口直也さんがTi2AlC MAX相セラミックスの社会実装を目的とした機械的特性と自己治癒能力評価というテーマでプロジェクトリーダー実習を行ってきました
卓越大学院プログラムGD3年山口直也さんが、茨城県つくば市にある物質・材料研究機構において、1月18日から約2か月のプロジェクトリーダー実習を行ってきました。実習テーマは「Ti2AlC MAX相セラミックスの社会実装を目的とした機械的特性と自己治癒能力評価験」というもので、長田俊郎 博士らの研究グループと共にTi2AlCの社会実装に必要な基礎物性の測定と、Ti2AlCの破壊挙動を観察するための装置の開発に関するプロジェクトを実施しました。これは、最先端材料であるTi2AlC MAX相セラミックスの社会実装を目的としたプロジェクトであり、ルートテクノロジーを体現したものとなりました。
![]() EDX・EBSDを⽤いて元素分析と結晶⽅位解析を⾏っている様⼦ |
![]() EPMAを⽤いて元素マップ作成を⾏っている様⼦ |
更新日:2021年3月31日
卓越大学院プログラムGD1年齋藤祐功さん、他Phoenix Robotsメンバーの活動が高等教育コンソーシアムにいがた発行の「ダイガクいろいろニイガタ2021」に取り上げられました
卓越大学院プログラムGD1年齋藤祐功さん(中山研、長岡高専出身)、他Phoenix Robotsメンバーが、本学も加盟している高等教育コンソーシアムにいがたの「ダイガクいろいろニイガタ2021」の「ニイガタでキラリ」のコーナーに取り上げられました。ダイガクいろいろニイガタは県内の高校、中学校や近隣の県の高校に配布されている新潟県内の高等教育機関紹介のパンフレットです。卓越大学院プログラム生が挑戦している活動ですので、多くの方にパンフレットを見ていただければと思います。
「ダイガクいろいろニイガタ2021」下記URLより閲覧可能(掲載面はP7)
https://consortium-niigata.jp/pamph/html5.html#page=7
https://consortium-niigata.jp/wp-content/uploads/2021/03/conso-guide.pdf
高等教育コンソーシアムにいがたHP
https://consortium-niigata.jp/
Phoenix RobotsのHP
https://phoenix-robots.com/
更新日:2021年3月31日
卓越大学院プログラムGD1年齋藤祐功さん、安原雅貴さん、沈志明さん他Phoenix Robots・INPUTメンバーが若者提案プロジェクト補助金に採択されました
卓越大学院プログラムGD1年齋藤祐功さん(中山研、長岡高専出身)、安原雅貴さん(南部研、長岡高専出身)、沈志明さん(中山研、中国出身)、他Phoenix Robots・INPUTメンバーが、本学も参画しているながおか・若者・しごと機構の若者提案プロジェクト補助金に長岡ものづくりフェアオンライン内の「ロボットエキシビションマッチ」を共同で提案し、採択されました。
長岡ものづくりフェアオンラインロボットエキシビションマッチ
下記URLより視聴可能
https://youtu.be/Tq_3Q3ReDNI
(ケーブルテレビのNCTでも随時再放送を実施)
エキシビションマッチに関するプレスリリース
https://prtimes.jp/main/html/rd/p/000000003.000073667.html
ながおか・若者・しごと機構のHP
https://n-wakamonokikou.net/index.html
Phoenix RobotsのHP
https://phoenix-robots.com/
INPUT のHP
https://input-ssl.dev/
更新日:2021年3月31日
卓越大学院プログラムGD1年齋藤祐功さん、安原雅貴さん、沈志明さん、他Phoenix Robots・INPUTメンバーが長岡市発行の「市政だより3月号」に掲載されました
卓越大学院プログラムGD1年齋藤祐功さん(中山研、長岡高専出身)、安原雅貴さん(南部研、長岡高専出身)、沈志明さん(中山研、中国出身)、他Phoenix Robots・INPUTメンバーが2021年2月13日に開催したロボットエキシビションマッチの様子を長岡市発行の「市政だより2021年3月号」に掲載されました。また、安原さん・齋藤さんのコメントがINPUTのコメントとして掲載されておりますので、ぜひご覧ください。
長岡市「市政だより2021年3月号」下記URLより閲覧可能(掲載面はP3)
https://www.city.nagaoka.niigata.jp/shisei/cate02/tayori/file/0303/0303pdf/02-03-798.pdf
https://www.city.nagaoka.niigata.jp/shisei/cate02/tayori/file/0303/0303pdf/798.pdf
イベント名
長岡ものづくりフェアオンラインロボットエキシビションマッチ
2021年3月31日まで視聴可能
https://youtu.be/Tq_3Q3ReDNI
(ケーブルテレビのNCTでも随時再放送を実施)
エキシビションマッチに関するプレスリリース
https://prtimes.jp/main/html/rd/p/000000003.000073667.html
Phoenix RobotsのHP
https://phoenix-robots.com/
INPUT のHP
https://input-ssl.dev/
更新日:2021年3月31日
卓越大学院プログラムGD1年齋藤祐功さん、他Phoenix Robotsメンバーが国際大会入賞を東学長に報告しました
卓越大学院プログラムGD1年齋藤祐功さん(中山研、長岡高専出身)、他Phoenix Robotsメンバーが2020年の夏に開催された国際大会 RoboMaster Technical Challengeに出場し、今回の大会で日本から唯一出場(オンライン)でThird Prizeを受賞したことを2020年12月23日に長岡技術科学大学 東信彦学長に報告し、活動拠点の見学をなど行いました。
![]() 東学長にロボットの説明の様子 |
![]() 東学長との集合写真 |
Phoenix Robots のHP
https://phoenix-robots.com/
更新日:2021年3月31日
卓越大学院プログラムGD1年齋藤祐功さん、他Phoenix Robotsメンバーが長岡市のロボコン大会の審判を務めました
卓越大学院プログラムGD1年齋藤祐功さん(中山研、長岡高専出身)、他Phoenix Robotsメンバーが2020年12月19日に開催された長岡市内対象の小学生ロボコン大会の審判並びにロボットのデモンストレーションを行い、小学生に操縦体験やロボットの仕組みについて説明を行いました。審判の様子が新潟日報(2021年1月5日)の朝刊に掲載されました。
![]() 操縦体験の様子 |
Phoenix Robots のHP
https://phoenix-robots.com/
更新日:2021年3月31日
卓越大学院プログラムGD1年齋藤祐功さん、他Phoenix Robotsメンバーが国際大会入賞を長岡高専原田校長に報告しました
卓越大学院プログラムGD1年齋藤祐功さん(中山研、長岡高専出身)、他Phoenix Robotsメンバーが2020年の夏に開催された国際大会 RoboMaster Technical Challengeに出場し、今回の大会で日本から唯一出場(オンライン)でThird Prizeを受賞したことを2020年11月4日に長岡工業高等専門学校原田信弘校長、鈴木秋弘副校長、荒木信夫校長補佐、外山茂浩校長補佐に報告、デモンストレーションなどをさせていただきました。Phoenix Robotsのメンバーには長岡高専の学生やOBが在団しているため、今回の報告が行われました。
![]() 報告の様子 |
![]() 原田校長がロボット操縦体験の様子 |
![]() 原田校長らとの集合写真 |
本報告を長岡高専HPでの掲載
http://www.nagaoka-ct.ac.jp/info/53448.html
Phoenix Robots のHP
https://phoenix-robots.com/
更新日:2021年3月31日
卓越大学院プログラムGD1年齋藤祐功さんがNEXT佐渡の会合に参加してきました
卓越大学院プログラムGD1年齋藤祐功さん(中山研、長岡高専出身)が2020年10月23日にあいぽーと佐渡で開催されたNEXT佐渡の会合に参加しました。会合では佐渡で起業した方・これから佐渡で起業する方などから発表を聴講しました。佐渡での起業などについて情報交換を行いました。
![]() |
更新日:2021年3月31日
卓越大学院プログラムGD1年齋藤祐功さん、他Phoenix RobotsメンバーがNaDeCBASEリニューアルオープン発表会に参加してきました
卓越大学院プログラムGD1年齋藤祐功さん(中山研、長岡高専出身)ら他Phoenix Robotsメンバーが2020年9月10日に開催されたNaDeCBASEのリニューアルオープン発表会に参加してきました。本学はNaDeC構想推進コンソーシアムに参画しており、長岡技術科学大学大石潔副学長、山口隆司学長補佐、長岡市水澤副市長らも参列いたしました。
![]() 集合写真 |
NaDeCBASEのHP
https://www.nadec-base.jp/
Phoenix RobotsのHP
https://phoenix-robots.com/
更新日:2021年3月29日
卓越大学院プログラムGD2年Shao Xuanyiさんが溶接学会の奨学賞を受賞しました
2021年2月2日、卓越大学院プログラムGD2年Shao Xuanyiさん(宮下研究室)の「難燃性マグネシウム合金の共材および異材接合のプロセスと接合体の強度信頼性評価」に関する研究の成果が認められ、溶接学会から奨学賞を受賞しました。
![]() |
更新日:2021年2月22日
卓越大学院プログラムGD1年齋藤祐功さん、安原雅貴さん、沈志明さん他Phoenix Robots・INPUTメンバーが長岡ものづくりフェアオンライン内でイベントを開催しました
卓越大学院プログラムGD1年齋藤祐功さん(中山研、長岡高専出身)、安原雅貴さん(南部研、長岡高専出身)、沈志明さん(中山研、中国出身)、技術科学イノベーション専攻GD1年小柏悠太郎さん(南口研、産技高専出身)ら他メンバーが、2021年2月13日に長岡ものづくりフェアオンライン内でロボットエキシビションマッチを行いました。
ロボットエキシビションマッチを開催し、その様子をケーブルテレビとYoutubeを通じて、全国・世界にオンライン生中継しました。中継を通じて子供たちなどにものづくりに興味を持っていただければと思っています。本イベントはSDGsのゴール9に関連する事業となっておりますので、ぜひご視聴ください。
<参加者よりコメント>
オンラインによる中継で通常では観ることのできないロボットの試合を提供できたと思います。試合や他のイベントを観て、少しでも子どもたちが「ものづくり」や「ロボット」などに興味を持っていただければ幸いです。今後も両団体は引き続き、子どもたちにものづくりの楽しさを伝える活動を続けていきたいと思っております。
![]() 開会式で齋藤さんが挨拶する様子 |
![]() INPUT (ロボカップサッカー)の中継の様子 |
![]() Phoenix Robots (Robo Master)の試合の様子 |
イベント名
長岡ものづくりフェアオンラインロボットエキシビションマッチ
2021年3月31日まで視聴可能
https://youtu.be/Tq_3Q3ReDNI
(ケーブルテレビのNCTでも随時再放送を実施)
エキシビションマッチに関するプレスリリース
https://prtimes.jp/main/html/rd/p/000000003.000073667.html
更新日:2021年2月22日
卓越大学院プログラムGD1年齋藤祐功さん、安原雅貴さん、他Phoenix Robots・INPUTメンバーがFM長岡の「ナガオカNGOK★」に出演しました
卓越大学院プログラムGD1年齋藤祐功さん(中山研、長岡高専出身)、安原雅貴さん(南部研、長岡高専出身)ら他メンバーが、2021年2月12日放送のFM長岡「ナガオカNGOK★」に出演しました。トークテーマは長岡ものづくりフェアオンライン開催の告知です。両団体はイベント内でロボットエキシビションマッチを行うため、ゲストとして出演しました。
![]() |
「ナガオカNGOK★」
https://www.city.nagaoka.niigata.jp/shisei/cate02/k-radio/ngok_2020.html
イベント名
長岡ものづくりフェアオンラインロボットエキシビションマッチ
2021年3月31日まで視聴可能
https://youtu.be/Tq_3Q3ReDNI
(ケーブルテレビのNCTでも随時再放送を実施)
エキシビションマッチに関するプレスリリース
https://prtimes.jp/main/html/rd/p/000000003.000073667.html
更新日:2021年2月22日
卓越大学院プログラムGD1年齋藤祐功さん、安原雅貴さん、他Phoenix Robots・INPUTメンバーがケーブルテレビのNCT「生中継ひなたのキャッチ・キャッチ」に出演しました
卓越大学院プログラムGD1年齋藤祐功さん(中山研、長岡高専出身)、安原雅貴さん(南部研、長岡高専出身)ら他メンバーが、2021年2月12日放送のケーブルテレビのNCT「生中継ひなたのキャッチ・キャッチ」に出演しました。収録内容は長岡ものづくりフェアオンライン開催の告知です。両団体はイベント内でロボットエキシビションマッチを行うため、イベント紹介として出演しました。
![]() ひなたと出演者との集合写真 |
「ひなたのキャッチ・キャッチ」
https://youtu.be/JFxWGtKoGGA
イベント名
長岡ものづくりフェアオンラインロボットエキシビションマッチ
2021年3月31日まで視聴可能
https://youtu.be/Tq_3Q3ReDNI
(ケーブルテレビのNCTでも随時再放送を実施)
エキシビションマッチに関するプレスリリース
https://prtimes.jp/main/html/rd/p/000000003.000073667.html
更新日:2021年2月22日
卓越大学院プログラムGD1年齋藤祐功さん、安原雅貴さん、他Phoenix Robots・INPUTメンバーが長岡市副市長らと長岡ものづくりフェアオンラインに向けて記者会見を行いました
卓越大学院プログラムGD1年齋藤祐功さん(中山研、長岡高専出身)、安原雅貴さん(南部研、長岡高専出身)、技術科学イノベーション専攻GD1年小柏悠太郎さん(南口研、産技高専出身)ら他メンバーが、2021年2月1日にNBICで長岡市高見真二副市長、長岡ものづくりフェア実行委員会柴木樹実行委員長らと記者会見を行いました。2月13日、齋藤さんらはものづくりフェアオンラインでロボットエキシビションマッチを行いました。
![]() 会見参列メンバーの集合写真 |
イベント名
長岡ものづくりフェアオンラインロボットエキシビションマッチ
2021年3月31日まで視聴可能
https://youtu.be/Tq_3Q3ReDNI
(ケーブルテレビのNCTでも随時再放送を実施)
エキシビションマッチに関するプレスリリース
https://prtimes.jp/main/html/rd/p/000000003.000073667.html
更新日:2021年2月22日
卓越大学院プログラムGD1年齋藤祐功さん、安原雅貴さんが長岡ロボットイノベーションハブのコアメンバーとして参加しました
卓越大学院プログラムGD1年齋藤祐功さん(中山研、長岡高専出身)、安原雅貴さん(南部研、長岡高専出身)が2020年9月から12月にかけて長岡産業活性化協会NAZEと長岡市が共同で立ち上げた、「長岡ロボットイノベーションハブ」に参加しました。ハブの活動では企業のロボット実装検討として、有限会社小林超固研磨が抱える課題解決策を提案するためにワーキンググループのオブザーバーとして参加し、2020年12月に検討した内容を報告しました。本活動はSDGsのゴール9に関連する活動となっております。
<参加者よりコメント>
実際の会社が抱えている問題を、学生だけではなく様々な分野で働いている会社の人たちと共通の課題を検討できたのは、大学では経験しにくいことだと思います。また、そこで得た経験を研究などに活用できればと思っています。
ロボットイノベーションハブの様子
・長岡市HP
![]() 参画メンバーとの集合写真 |
![]() ディスカッションの様子 |
更新日:2021年2月17日
卓越大学院プログラムGD2年山口直也さんがGordon Research Conference on High Temperature Corrosionに参加しました
2019年7月21日~26日、卓越大学院プログラムGD2年山口直也さんが GRC on High Temperature Corrosionに参加しました。Gordon Research Conference : GRC はサイエンスの分野で歴史と権威のあり、広く知られている研究集会の一つです。全ての参加者がGRC内で行われた議論の内容を外部に漏らさないという制約があるため、外部発表前の重要な研究成果を徹底的に議論できる環境が保証されています。GRCに参加したことにより、様々な分野のまだ公にされていない最先端の研究成果を学ぶことが出来ました。
![]() GRC集合写真 |
更新日:2021年2月8日
卓越大学院プログラムGD4年中村彰宏さん(小笠原研、新発田南高校出身)が新発田市長と菊水酒造株式会社社長、IBシステム株式会社社長を表敬訪問しました
卓越大学院プログラムGD4年中村彰宏さん(小笠原研、新発田南高校出身)と技術科学イノベーション専攻GD3年北原雪菜さん(長岡高校出身)ら5名の学生と小笠原教授、山口教授、中山教授が2021年2月5日にヨリネス新発田( 新発田市新市庁舎 )にて、二階堂 馨市長と菊水酒造株式会社 高澤大介社長、IBシステム株式会社 若桑茂社長と面会し、新発田市における食品工業および製造業活性化策について話し合いました。更に、学生5名は菊水酒造株式会社を訪問し、菊水日本酒文化研究所において、酒造メーカーにおける新製品開発と「ことづくり」、持続可能なビジネスモデルに関する意見討論を行いました。
![]() ヨリネス新発田における市長訪問時の写真 |
![]() 菊水日本酒文化研究所の視察の様子 |
更新日:2021年2月4日
卓越大学院プログラムGD4年中村彰宏さん、杉山大晴さん、長尾和樹さんが、TeNYテレビ新潟”SDGs特集”で本学のSDGs達成に向けた本学の活動やSDGsゲームに関して説明しました
2021年1月19日、卓越大学院プログラムGD4年中村彰宏さん(小笠原研、新発田南高校出身)、杉山大晴さん(中山研、鹿児島高専出身)、長尾和樹さん(江研、香川高専出身)が、TeNYテレビ新潟”SDGs特集”で本学のSDGs達成に向けた活動や本学が開発したSDGsゲームに関して説明しました。SDGsの達成につながる本学の研究についても知っていただくことが出来たと感じています。
この様子は2021年1月29日にTeNYテレビ新潟、夕方ワイド新潟一番にて放送されました。
![]() |
![]() |
更新日:2021年2月4日
卓越大学院プログラムGD3年長尾和樹さんが、ながおか・若者・しごと機構と VIVITA株式会社主催のVIVITA ROBOCON 2019 SUMMER in NaDeC BASEにて技術協力を行いました
2019年9月21日、卓越大学院プログラムGD3年長尾和樹さんと竹村元気さん(機械創造工学課程4年)が、ながおか・若者・しごと機構とVIVITA株式会社主催のVIVITA ROBOCON 2019 SUMMER in NaDeC BASEにて技術協力を行いました。このイベントはVIVITA株式会社の新世代クリエイティブツールセットとレーザー加工機用いて、長岡市内の小学生11人が自由な発想でオリジナルロボットを製作しコンテストに参加しました。子供たちのアイディアを形にするため、ハード面、ソフト面の両方からロボット制作をアシストしました。
![]() |
![]() |
更新日:2021年2月4日
卓越大学院プログラムGD2年長尾和樹さんが、NPO法人 長岡産業活性化協会NAZE主催のモノづくりコンペに参加しました
2019年2月9日・10日、卓越大学院プログラムGD2年長尾和樹さん(江研、香川高専出身)が、長岡高専の小黒さんと共同でNPO法人 長岡産業活性化協会NAZE主催のモノづくりコンペに参加しました。このコンペは企業から出された課題に対し、企業と共同で課題解決に取り組むものです。
アクリル加工を得意とする長岡市内の企業(株)クワバラと共同で、七変化する長岡花火を楽しめるオブジェの開発を行いました。
![]() |
![]() |
更新日:2021年2月3日
卓越大学院プログラムGD4年杉山大晴さん(環境・プロセスデザイン研究室、鹿児島高専出身)が5th STI-Gigakuにて実行委員長を務めました
2020年10月30日・31日に開催された5th STI-Gigakuにて実行委員長を務めました。また、多くの卓越大学院プログラムの学生が実行委員として本国際会議の運営を行いました。コロナ禍の中、現地とオンラインのハイブリッドの開催となりましたが、どちらの会場でも活発な議論が行われました。また、本取り組みが記事として新潟日報に取り上げられ、杉山大晴さんのコメントも掲載されました。
![]() 実行委員長の挨拶の写真 |
更新日:2021年1月29日
卓越大学院プログラムGD2年三輪(曾我)徹さんの査読付き論文”Role of live cell colonization in the biofilm formation process in membrane bioreactors treating actual sewage under low organic loading rate conditions”が国際学術雑誌Applied Microbiology and Biotechnology に掲載されました
2021年1月23日、卓越大学院プログラムGD2年三輪(曾我)徹さん(山口研究室)の査読付き論文 ”Role of live cell colonization in the biofilm formation process in membrane bioreactors treating actual sewage under low organic loading rate conditions” が国際学術雑誌 Applied Microbiology and Biotechnology に掲載されました。実下水を処理する膜分離活性汚泥法で発生するバイオフィルムの形成過程を詳細に調査しました。
![]() 実験の様子 |
更新日:2021年1月29日
卓越大学院プログラムGD2年三輪(曾我)徹さんが文部科学省よりトビタテ留学ジャパン同窓会コミュニティとまりぎ北信越地域代表へ任命されました
2020年10月1日、卓越大学院プログラムGD2年三輪(曾我)徹さん(山口研究室)が、文部科学省よりトビタテ留学ジャパン同窓会コミュニティとまりぎの北信越地域代表へ任命されました。
![]() 任命書 |
更新日:2021年1月29日
卓越大学院プログラムGD1年三輪(曾我)徹さんが、ながおか・わかもの・仕事機構主催「新商品開発ワークショップ」に参加しました
2019年8月から2020年1月にかけて、卓越大学院プログラムGD1年三輪(曾我)徹さん(山口研究室)が、ながおか・わかもの・仕事機構主催「新商品開発ワークショップ」に参加しました。長岡市内4大学の学生のチームでリーダーを務め、観光客向けの新しい米菓のアイディアを提案し、商品化まで決まりました。※2020年7月から販売予定でしたが新型コロナウイルスの影響によりプロジェクトは凍結中。
![]() 米菓フェスにて新商品の試作品を提供 |
更新日:2021年1月29日
卓越大学院プログラムGD1年三輪(曾我)徹さんが”SDGsとエネルギー”をテーマとした「わくわくどきどき科学教室 In 長島 2019」にて「ジュースが透明に!?―水の中の粒子を取り除こう―」を東レ株式会社の協力のもと出展しました
2019年7月27日(土)・28日(日)、卓越大学院プログラムGD1年三輪(曾我)徹さん(山口研究室)は鹿児島県長島町で子どもたちを対象に、科学の面白さを体験してもらうために開催された「わくわくどきどき科学教室 in 長島 2019」において、「ジュースが透明に!?―水の中の粒子を取り除こう―」を出展しました。実験や交流を通して科学の楽しさを伝えることができたと思います。
![]() 「ジュースが透明に」の実験後の膜を観察 |
更新日:2021年1月29日
卓越大学院プログラムGD1年 三輪(曾我)徹さんがThe Water and Environment Technology Conference にて The WET Excellent Presentation Awardを受賞しました
2019年7月13日、水圏土壌環境研究室卓越大学院プログラムGD1年三輪(曾我)徹さん(山口研究室)の発表「Effect of different microbial community of activated sludge on occurrence of membrane fouling in A/O-MBR」が日本水環境学会が主催する国際学会 The Water and Environment Technology Conference2019(WET2019)にて The WET Excellent Presentation Award を受賞しました。
![]() 研究室の先生、仲間との集合写真 |
更新日:2021年1月29日
卓越大学院プログラムGD1年三輪(曾我)徹さんが、起業家&SDGsセミナー「入学して即起業!?スペイン・バスク州で学ばれている起業家精神とは?」を長岡市、NPO法人まちなか工房、ガストロノミー研究会と連携し企画・運営を行いました
2019年4月18日、卓越大学院プログラムGD1年三輪(曾我)徹さん(山口研究室)が、起業家&SDGsセミナー「入学して即起業!?スペイン・バスク州で学ばれている起業家精神とは?」を長岡市、NPO法人まちなか工房、ガストロノミー研究会と連携し企画・運営を行いました。スペインのバスク州と日本を繋ぐ活動をしている起業家 JonAnder氏、UONI料理長の西澤敬介さん、長岡造形大学教授渡邊誠介さんとともに「起業家精神」から生まれる新しい「長岡食」の動きをテーマにトークセッションをしていただきました。総勢20名前後の参加者とともに積極的な交流を行いました。
![]() 参加者と講演者との集合写真 |
更新日:2021年1月29日
卓越大学院プログラムGD2年 大畠慶太さん(パワーエレクトロニクス研究室、茨城高専出身)が国際学会IPEMC2020 にてBest Paper Awardを受賞しました
2020年11月29~12月2日に行われたIPEMC2020(2020 IEEE 9th International Power Electronics and Motion Control Conference)において、パワーエレクトロニクス研究室(伊東研究室)卓越大学院プログラムGD2年 大畠慶太さんの発表「Decentralized Control Using Wireless Signal Communication for Solid-state Transformer with Cascaded Chopper Cell」がBest paper awardを受賞しました。Best paper awardはIPEMC2020に応募のあった発表604件のうち20件が受賞しました。
![]()
|
更新日:2021年1月29日
卓越大学院プログラムGD3年渡利友紀さんが長岡市和島地域における持続可能な公共交通に関する調査を行いました
2020年9月21日~10月15日、長岡市役所と共同で和島地域において、持続可能な公共交通に関する調査を行いました。過疎地域である和島地域では、自家用車保有率が高く公共交通の運営が厳しい状況に置かれていますが、今後、少子高齢化が進むことにより、自家用車の利用が低下し公共交通の重要度が高まると予想されます。
そこで本調査では持続可能な公共交通として、運行自由度が高い乗合タクシーに注目して調査を行いました。
更新日:2021年1月29日
卓越大学院プログラムGD2年渡利友紀さんが、タイ・バンコクにおける交通型サブスクリプションMaaS(Mobility as a Service)というテーマで海外リサーチインターンシップを行いました
タイ王国のアジア工科大学院(Asian Institute of Technology)において、2019年9月から約4ヶ月間、Dr. Kunnawee Kanitpongの研究室で「バンコクにおける交通型サブスクリプションMaaS(Mobility as a Service)」というテーマで、海外リサーチインターンシップを行いました。バンコクでは自家用車の増加に伴う渋滞発生により、環境問題や物流効率の低下が問題になっており、公共交通の利用促進が急務となっており、今回はMaaSに着目した研究を行いました。
海外での研究では言葉、文化の違い等で苦労しましたが、研究遂行力及び社会実践能力を向上させることができました。
![]()
|
![]()
|
更新日:2021年1月29日
卓越大学院プログラムGD1年片岡翔太郎さんが、経済産業省による委託事業「L-Creator’s Bridge」プログラムの高度 IT 人材に採用されました
経済産業省委託事業「L-Creator’s Bridge」は、地域と独創的なアイデアや IT に関する専門性を持つ高度人材(高度 IT人材)が連携・協働する新たなスキームを作ることで地域課題の解決を目指す社会実験プロジェクトです。この調査対象地域としては長岡市と札幌市が選定されており、フェアリーデバイセズ株式会社と長岡技大の学生(卓越大学院プログラムGD1年片岡翔太郎さん、他1名)の混成チームの一人として長岡市で実施される本事業に応募し採択されました(採択は2チーム)。現在、 伝統工芸における技術伝承を行うための熟練技術者の作業分析システムをチームメンバーと開発中です。
更新日:2021年1月29日
卓越大学院プログラムGD1年片岡翔太郎さんが、研究成果の実用化を目指すベンチャー企業「株式会社マヨラボ」を設立
卓越大学院プログラムGD1年片岡翔太郎さんの研究テーマである作業動画を機械学習に用いて作業内容を推定する技術は製造業における現場の作業分析などに利用でき産業界でのニーズも大きいです。そこで代表取締役として自身の研究成果の実用化をはかるベンチャー企業「株式会社マヨラボ」を2月に設立します。
更新日:2021年1月25日
トビタテ!留学JAPAN 同窓会コミュニティとまりぎにて卓越大学院プログラムGD3年 大川采久さん(環境・プロセスデザイン研究室、苫小牧高専出身)が全体運営代表に任命されました
2020年10月1日、環境・プロセスデザイン研究室(中山研究室)卓越大学院プログラムGD3年 大川采久さんが文部科学省よりトビタテ!留学JAPAN 留学生同窓会コミュニティの全体運営代表に任命されました。
![]() とまりぎ運営 全体コア代表任命状 |
更新日:2021年1月25日
日本セラミックス協会 第33回秋季シンポジウムにて卓越大学院プログラムGD3年 大川采久さん(環境・プロセスデザイン研究室、苫小牧高専出身)の発表がセッション賞を受賞
2020年9月4日、環境・プロセスデザイン研究室(中山研究室)卓越大学院プログラムGD3年 大川 采久さんの発表「Improvement of water vapor cosorrion resistance by adding SiC to Yb2Si2O7 ceramics」が公益社団法人日本セラミックス協会 第33回秋季シンポジウムでセッション賞を受賞しました。
![]() Material Design and Processing Design Session 敢闘賞 |
![]() |
更新日:2021年1月19日
日本農芸化学会にて卓越大学院プログラムGD4年 中村彰宏さん (発酵科学研究室、新発田南高校出身)の発表が学会トピックス賞に選出
2020年3月28日、発酵科学研究室(小笠原研究室)卓越大学院プログラムGD4年 中村彰宏さんの発表「抗菌薬開発に資する Porphyromonas gingivalis 由来Dipeptidyl peptidase 11の構造解析と阻害化合物探索」が日本農芸化学会2020年度大会で学会トピックス賞および優秀ポスター賞に選出されました。日本農芸化学会の学会トピックス賞は年次大会の一般講演登録演題(例年約2,500題)より約30題を大会実行委員会と広報委員会が選定するものです。
![]() ポスター賞および学会トピックス賞証書 |
更新日:2021年1月8日
卓越大学院プログラムGD4年 中村彰宏さん (発酵科学研究室、新発田南高校出身)の酵素サンプルがスペースXファルコン9ロケットで国際宇宙ステーションへ出発
発酵科学研究室(小笠原研究室)で研究を進めている、卓越大学院プログラムGD4年 中村彰宏さんがサンプル調整した”バクテリアのみが生産するタンパク質分解酵素”が、12月6日にフロリダのケネディ宇宙センターからスペースXファルコン9ロケットでISS(国際宇宙ステーション)に向けて打ち上げられました。今後は、ISSにて高解像度の結晶構造を得るための結晶化実験が行われ、1月11日に地上に帰還予定です。帰還後はX線結晶構造解析により、タンパク質分解酵素の構造解析を試みます。
![]() 国際宇宙ステーション(ISS)©NASA/JAXA |
![]() 前回の宇宙実験で結晶化されたサンプルの画像©岩手医科大学 |
更新日:2020年11月17日
Practical work for project leader education at National Institute for Environmental Studies, Tsukuba Science City
Ms. Tran Phuong Thao, GD4 (fourth year student of the WISE program), has done her two-month internship for “Practical work for project leader education” subject at Center for Regional Environmental Research, National Institute for Environmental Studies in Tsukuba Science City, the city is known as The Japan’s Center of Research and Development. Her research topic is “Evaluation of biological wastewater treatment technology” with Prof. Syutsubo Kazuaki. Prof. Syutsubo’s team has many international collaboration projects to implement the advanced technology from laboratory to industrial-scale system and assess their impacts on society and economics in not only Japan but oversea countries (e.g. Vietnam, Thailand, Egypt, India, etc.). This internship provided a valuable learning experience, both interpersonal (i.e., learning Japanese for workplace, making new friends) and professionally (i.e., developing a research idea into applicable technology).
国立環境研究所でのプロジェクトリーダー実習報告
国立研究開発法人国立環境研究所 地域環境研究センターにおいて、珠坪一晃先生らの研究室で9月7日から「生物学的排水処理技術の評価に関する研究」をテーマに約2か月のプロジェクトリーダー実習を行ってきました。珠坪先生のチームは、研究室から工業規模のシステムまで高度な技術を実装し、日本だけでなく国外(ベトナム、タイ、エジプト、インドなど)における社会経済への影響の評価など、数多くの国際協力プロジェクトを行なっています。本実習において研究所職員の方とのコミュニケーション及びディスカッションを通して、自らの日本語能力と社会性の向上につなげることができ、大変貴重で有意義でした。
技術科学イノベーション専攻 4年 Tran Phuong Thao
![]() |
![]() |
更新日:2020年10月28日
卓越大学院プログラムGD3年大川 采久君(中山研、苫小牧高専出身)が佐渡空港において電動航空機(無人電気飛行機)の実証試験を行いました
卓越大学院GD3の大川 采久君(中山研、苫小牧高専出身)が電動航空機を用いて、2016年8月からドローンやロボットの遠隔操作に利用できるようになった169MHz帯の電波の電波伝搬実証試験を佐渡空港において実施しました。
10月28日には総務省 信越総合通信局の杉野局長や佐渡工業会の林田会長らが見学する中、169MHz帯の基地局と通信局の間のハンドオーバー試験を行いました。
この技術が確立することにより、技術的には数十kmの長距離の電動航空機の運用が可能になります。
本実験は東京農工大学、新明和工業(株)、NICT(情報通信研究機構)、一般財団法人 総合研究奨励会との共同事業となります。
このように卓越大学院プログラムにおいては、材料科学と電気工学と情報科学の融合したルートテクノロジーに関する実践的な取り組みに挑んでいます。
![]() 佐渡空港の外の加茂湖上空を飛行する電動航空機( |
更新日:2020年9月24日
学生団体Phoenix Robotsメンバー(卓越大学院プログラム1年齋藤祐功さん他)が磯田達伸長岡市長を表敬訪問しました
令和2年9月14日(月)に学生団体Phoenix Robotsのメンバー4名(本学卓越大学院プログラム1年齋藤祐功さん、機械創造工学課程4年山岸開さん、情報・経営システム工学専攻1年小黑司友さん、電気電子情報工学専攻1年江坂壮平さん)が磯田達伸長岡市長を表敬訪問しました。
「Phoenix Robots(フェニックスロボッツ)」はRoboMaster(ロボマスター)出場を目指し今年3月に設立されたロボット研究開発を行う学生団体で、本学の学生を中心に、長岡高専、新潟大学の学生約40名で活動しています。この度中国で開催された国際大会 RoboMaster Technical Challengeに長岡から初めて、また今回の大会で日本から唯一出場(オンライン)し、ロボットの技術力が高く評価されたことから、磯田市長を表敬訪問し大会の結果と活動の報告を行いました。
参加メンバーより
今年度はコロナの影響により中国本土での大会は無くなり、オンライン大会になりました。本望とは異なる大会形式ですが、日々の活動が実って設立約半年で国際大会に出場することができました。ここまで活動を行うことができたのは、大変な時期にも関わらず、ご協賛・ご協力いただいた企業様、長岡市様を始めとする皆様方のおかげだと感じています。
チームの活動を通し、世界大会に挑戦すると共に、地元の小学生などにモノづくりの楽しさを伝える活動などを行いたいと思っております。また、モノづくりを通して得た技術などを用いて産業にイノベーションを起こせるよう尽力いたします。
今後もさらに長岡市をはじめとする様々な方々と連携し、チームの力を強めていきたいと考えています。
Phoenix Robots HP:https://phoenix-robots.com/
![]() |
更新日:2020年5月15日
射出成型・ゲルキャスティング・ゾルゲル法を融合した新規セラミックス複雑形状多孔体のプロセスデザイン
ドイツのFriedrich-Alexander-Universität Erlangen-Nürnberg (FAU)において、Prof. Dr. Feyらの研究室で2月13日から3月14日まで「射出成型・ゲルキャスティング・ゾルゲル法を融合した新規セラミックス複雑形状多孔体のプロセスデザイン」のテーマで約1か月の海外リサーチインターンシップを行ってきました。これは、セラミックスの多孔質に注目した研究です。異国で異なる研究環境に身を置き、文化に基づいた研究に対する考えた方を学びました。新たな角度から研究活動を俯瞰することで、学術領域開拓力および社会実装実践力を培うことができました。
技術科学イノベーション専攻 3年 大川 采久
![]() |
![]() |
更新日:2020年4月9日
卓越大学院プログラム1年 片岡翔太郎さんが、AIフロンティアプログラムのAIフロンティアパスファインダー(共働)の称号を授与されました
国立研究開発法人新エネルギー・産業技術総合開発機構(NEDO)の委託を受けて一般社団法人未踏財団が実施する、AIフロンティアプログラムの第1期報告会において、技術科学イノベーション専攻1年(受賞当時:情報・経営システム工学課程4年)片岡翔太郎さんが、AIフロンティアパスファインダー(共働)の称号を授与されました。
【プログラムと受賞概要】
本プログラムは、AI技術を駆使してイノベーションを創出することのできる独創的なアイデアや技術を有し、これらを活用する優れた能力を持つ若い人材を、公募等を通じて発掘したうえで、AI分野における実践的能力を高度化するために必要な資源の提供に加え、伴走型で研究開発支援や技術・経営等に関するアドバイスの提供等の支援を行い、突出した人材を育成するプログラムです。
AIフロンティアパスファインダーは、その中で特に優れた能力を有し、リーダーシップと突破力を兼ね備えた人材に対して、これからのAI分野を牽引していく存在として授与される称号です。
【研究概要】
片岡さんは、昨年より吉崎航氏(アスラテック株式会社取締役/チーフロボットクリエイター)の指導のもと、「作業工程分析を支援するための教師なし作業検出手法の開発」のテーマで研究を進め、今回の発表を行いました。
これは工場などでの作業内容を、AI技術を用いて分析する研究であり、生産効率の向上などに役立つことが期待されています。本研究では従来の分析手法に比べ、低コスト・短期間で分析ができる手法の開発を目指しました。
![]() 成果報告会の様子1 |
![]() 成果報告会の様子2 |
![]() 成果報告会の様子3 |
更新日:2020年4月9日
組成と添加元素を変えたTi-Al-C系MAX相セラミックスの長期大気酸化実験
ポーランドにあるAGH University of Science and Technologyにおいて、1月15日から約2か月の海外リサーチインターンシップを行ってきました。実験テーマは「組成と添加元素を変えたTi-Al-C系MAX相セラミックスの長期大気酸化実験」というもので、Dr. Tomasz Brylewskiらの研究室で研究を行いました。
これは、最先端材料であるMAX相セラミックスに注目した研究であり、ルートテクノロージーを体現したものとなりました。
技術科学イノベーション専攻 3年 山口 直也
![]() TG測定の様子 |
![]() 酸化処理実験の様子 |
最適な構造を数値的に求めるために用いられるトポロジー最適化の数値実験
スペインのPolytechnic University of Catalonia(UPC)の建築学科において、Prof.Joan Baigesの研究室で1月5日から3月9日まで海外リサーチインターンシップを行ってきました。研究テーマは「トポロジカルデリバティブに基づくトポロジー最適化の取得および数値実験」です。トポロジー最適化とは、ある条件下である程度の性能を維持するための最適な構造を数値的に求める手法の1つであり、他の最適化手法と比べ最も自由度が高く、数値的に最適な構造をもとめることのできる手法です。近年、電子機器や建築物、機械部品など様々な分野に使用されている技術です。建築学科という異分野にて様々な国の博士学生と研究ができ、学術領域開拓力および社会実装実践力のための様々な知識と経験が得られました。
技術科学イノベーション専攻 1年 岸田 真幸
![]() |
![]() |
最先端加速器などに用いられる特殊な構造を持つ電極の開発
Center for Pulsed Power and Power Electronics, Texas Tech Universityにおいて、Prof. James C. Dickensらの研究室で11月18日から「最先端加速器などに用いられる特殊な構造を持つ電極の開発」のテーマで約3か月半の海外リサーチインターンシップを行ってきました。これは、最先端加速器の電極材料に注目した研究であり、ルートテクノロージーを体現したものとなりました。
技術科学イノベーション専攻 3年 長尾 和樹
![]() |
![]() |
The delegate at the 12th international conference on the “Challenges in Environmental Science and Engineering” (CESE-2019)
The CESE-2019 conference was held in Kaohsiung, Taiwan, from 3rd to 7th November 2019. This conference gathers researchers, policy-makers, academics, students from around the world to contribute solutions to the myriad of environmental questions, such as advanced technology for sustainability & climate change adaptation, soil – air – water pollution prevention and treatment.
The oral presentation of students and young scientists was allocated in three parallel sessions on 5th November. Our GD3 student, Ms. Tran Phuong Thao presented the study entitled “Evaluation of DAMO process performance and nexus of N2O emission in a DHS reactor” and won the award for “Best student oral presentation award” (among 84 presentations, 6 presentations chosen for Best student oral presentation and 4 presentations chosen for Best young scientist oral presentation).
In the CESE-2019 conference, I also participated in the “Scientific writing and speed sparring workshop” facilitated by Dr. Eldon R. Rene from IHE Delft Institute for water education, on 4th and 6th November 2019.
12th international conference on the “Challenges in Environmental Science and Engineering” (CESE-2019)への参加
2019年11月3日~7日、台湾で開かれた12th international conference on the “Challenges in Environmental Science and Engineering” (CESE-2019)に参加しました。この会議では、世界中の研究者、政策立案者、学者、学生を集めて、持続可能性と気候変動への適応のための先進技術、土壌・空気・水質汚染の防止と治療など、無数の環境問題の解決を目的に開催されています。
私は3日目に”Evaluation of DAMO process performance and nexus of N2O emission in a DHS reactor”をテーマに発表し、“Best student oral presentation award” (84人中6人)を受賞することができました。このような賞をいただくことができ、大変光栄に思います。
この学会を通じて、IHE Delft Institute for water education のDr. Eldon R. Rene が担当していた“Scientific writing and speed sparring”というワークショップも参加させていただきました。
今回の受賞を励みに、今後もさらなる成果を挙げられるよう精進します。
技術科学イノベーション専攻 3年 Tran Phuong Thao
|
|
次世代医療用ロボットに関する日英連携研究
イギリスのシェフィールド大学において、小型ロボットの磁場制御に関する研究を行っています。この研究は、私が日本でこれまで研究してきた電磁場解析や材料工学に関する知見と、シェフィールド大学が有するマイクロロボット工学に関する知見を融合させた、ルートテクノロジーを体現する研究となっています。将来、この技術が医療分野でのイノベーションにつながると確信しています。
技術科学イノベーション専攻 3年 杉山 大晴
![]() 折り紙型ロボットの制御装置の設計の打ち合わせ(写真左) |
![]() シェフィールド大学マイクロロボティクス研究室のメンバーとの集合写真(写真中央) |